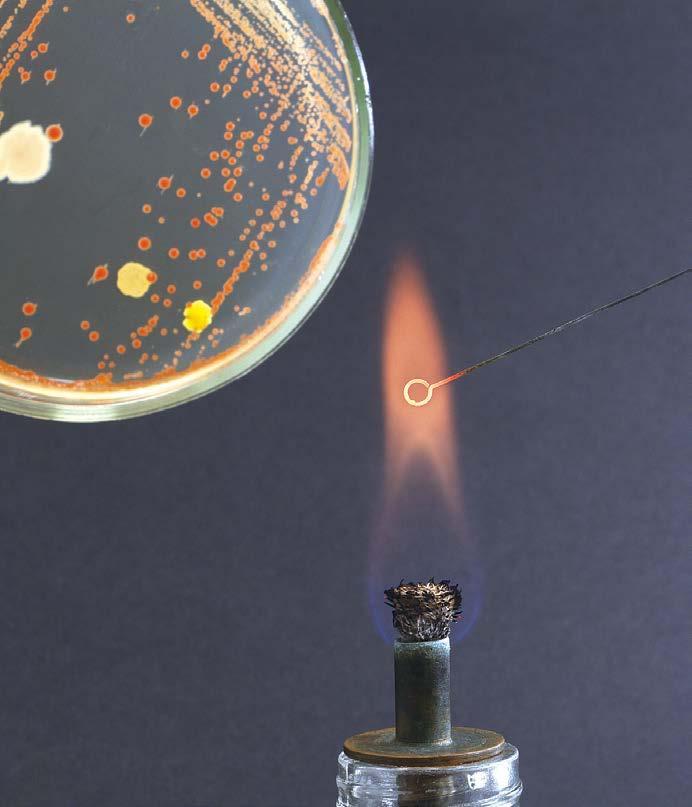

NZ’S AUTHORITY ON FOOD TECHNOLOGY, RESEARCH AND MANUFACTURING THE OFFICIAL JOURNAL OF THE NEW ZEALAND INSTITUTE OF FOOD SCIENCE AND TECHNOLOGY INC. Foodtech Packtech Exhibition preview EQI, an assay for measuring bioactivity of bovine whey proteins NZFSSRC – Annual Symposium Report NZIFST Strategy Refresh NZIFST CONFERENCE 2023 AWARDS August/September 2023 FEATURED IN THIS ISSUE:
AUGUST/SEPTEMBER 2023 | VOLUME 23, NO.4 ISSN 2744-7308 (ONLINE) ISSN 1175-4621 (PRINT)

John D Brooks
Director and Editor

Anne Scott, Peppermint Press Limited anne@foodnz.co.nz
Director and Writer
Dave Pooch, Peppermint Press Limited davep@me.com
Advertising
Anne Scott, anne@foodnz.co.nz 021 901 884



Design and Layout
Johanna Paynter, Pix Design
Published by Peppermint Press Limited
Notice to Contributors
When submitting editorial for Food New Zealand please observe the following, Editorial to be submitted as plain text files, NO FORMATTING please. Images should be sent as high resolution .jpg or .tiff files. Do not embed images in word documents, send separate files. Any images smaller than 500 kb may not be printed as the clarity of the print may be compromised.
Advertisers
Material specification sheet and rate card on website, www.foodnz.co.nz
Copyright © 2023 Peppermint Press
No part of this publication may be reproduced or copied in any form by any means (graphic, electronic, or mechanical, including photocopying, recording, taping information retrieval systems, or otherwise) without the written permission of Peppermint Press. The views expressed in this journal are those of the writers and do not necessarily represent the view of the Publisher, the Scientific Review Board or NZIFST
Regular Contributors
Phil Bremer, John D Brooks, Laurence Eyres, Ben Sutherland, Dave Pooch, John Lawson
Food New Zealand 2 NZ’S AUTHORITY ON FOOD TECHNOLOGY, RESEARCH AND MANUFACTURING Contents 4 EDIT ORIAL 5 NEW SBITES 10 FSANZ
International Symposium on cell-based fFood ingredients Ben Sutherland, Principal Food Technologist, Standards & Surveillance, FSANZ 11 NZ FOOD SAFETY Celebrating New Zealand’s success at Codex: 60 years and beyond 12 OILS & FATS Oils and Fats update Laurence Eyres FNZIFST 14 CAREERS
NZIFST Salary Survey
Recruitment 15 J C ANDREWS AWARD
2023
2023
John Lawson, Lawson Williams
J C Andrews Address 2023
Contacts
Press Ltd 5 Rupi Court, Mt Wellington Auckland
is distributed
to
members
the
tute of
Science and Technology. An online edition is shared internationally. Visit www.foodnz.co.nz to subscribe.
Peppermint
1072, New Zealand Phone 64 21 901 884 www.foodnz.co.nz Food NZ
online
all
of
New Zealand Insti-
Food
15 11 5
Executive Manager, Wendy Bayliss
PO Box 44322
Pt Chevalier Auckland 1022
New Zealand
Phone: 022 549 8483, Email: wendy@nzifst.org.nz
Website: www.nzifst.org.nz
22 FTPT
Foodtech Packtech 2023: Unveiling the Future of Food Innovation
29 PACKAGING
AIP will offer a packaging forum and a training course alongside Foodtech PackTech 2023

30 NZFSSRC
NZFSSRC Food Safety Symposium Wrap


33 RESEARCH
EQI, an assay for measuring bioactivity of bovine whey proteins
Katharine Adam, Grant Smolenski, Colin Ogle, Rodney Claycomb
36 NZIF ST N EWS INCLUDING
Strategy Refresh NZIFST AGM 2023
Awards Branch News
50 STUDENT ESSAY
Precision Fermentation: Cultivating the future of dairy

Erin Lau, Student, The University of Auckland, Food Science Programme

JOIN NZIFST NOW for Professional Development Networking – connecting with your peers
Regular information about your industry
Recognition through awards, scholarships, travel grants www.nzifst.org.nz/join/
On the cover
Cover image: The culmination of the NZIFST year – a conference in Dunedin and an awards dinner in the imposing Dunedin Town Hall.

Next editorial and advertising deadline: September 20th, 2023

Features for October/November 2023
Cloud-based monitoring and management
Food ingredients overview
Packaging update
June / July 2023 3
36 30 12 50 14 22
Finding your tribe – your network
For millennia mankind has lived within tribes. In prehistory a family, or tribe provided security, both physical and nutritional. As time passed members of a tribe adopted individual roles which supported those around them and tribes grew beyond direct family ties.
We still need our tribe. In our miraculously interconnected world we still need to be connected, personally, with people we like to be around, who are socially congenial, with whom we share a common link.
In the case of NZIFST we are all connected by our knowledge and relationship with food, whether in production of food products, ensuring the safety of our food products, in research into food structure, digestion, flavour –and many more aspects of the food system that sustains our society.
Outside our technical focus, we have interractions with colleagues whose roles connect with ours. We couldn’t develop and market a new formulation without ingredient suppliers, without our costing and production personnel.
Our recent Conference in Dunedin reinforced the interconnectedness amongst members of our industry. One degree of separation is the norm, admittedly enhanced by our small nation.
Many members are connected internationally, through postings and early studies overseas, and they maintain those links to support the New Zealand industry.
As a member of NZIFST I treasure the tribe I joined when I arrived at Massey University in Palmerston North in 1971. Our Institute was incorporated at Massey in 1965 and has developed into a dynasty of networked, supported individuals.
Over the years I have benefited from the networks of my teachers, supervisors, colleagues and peers. I have been able to support others in their own endeavours. In early days I was amazed and somewhat intimidated by Mary Earle’s network. “Ask Mary (Earle) anything and if she doesn’t know she will know who to recommend.” I now realise that Mary’s network was the product of many active years working with her tribe. So here’s my point.
NZIFST is a network of people who will help you build your career. They will help you achieve your goals. But remember, it’s not a one-way road. A network is just that, connections travel in both directions, just like a thriving friendship.
Our Board and Exec are working on an extensive project to refresh the NZIFST brand. Their areas of study are
• Membership: How do we engage with our current membership base?
• Financial: How do we ensure real benefits for our members?
• Partnerships: How do we have strategic partnerships that bring benefits to our members?
• Image: How do we remain relevant in our branding and communications?
• Growth: How do we grow our membership base?
Our President, Esraa Ell Shall and the team are looking for volunteers. If you want to join the NZIFST network you will be making an excellent start if you participate in this project. You will find more about the Strategy Refresh on page 36.
Anne Scott FNZIFST, Editor

Food New Zealand 4 EDITORIAL Editorial
Anne Scott FNZIFST, Editor
Newsbites
Food New Zealand’s round up of news about NZIFST members, associated companies and other items of interest.

Meat still on menu despite challenges
More than nine out of ten New Zealanders are meat-eaters, a survey has found; although almost half of Kiwis have reduced their meat consumption in response to issues such as cost and health.
The results of the online survey carried out in December 2021 – along with an associated review led by crown research institute AgResearch – shows high awareness of meat alternatives, but a “very low” level of consumption of those alternative products.
The study concludes that overall, the outlook for meat consumption and the meat industry in New Zealand is positive and is likely to remain so for the foreseeable future. The study was conducted by AgResearch scientists and Lincoln University researchers.
The online survey of 1061 New Zealand consumers found that for meat-eaters “the taste of meat is the king decider for purchase and consumption”; with 71% rating taste a “very important” attribute when purchasing, followed by price (55%) and use-by date (51%). Results showed that chicken was the main type of meat consumed regularly, accounting for about 33% of the meals within an average week, followed by beef (22%), fish (13%), pork (10%), lamb (8%), and processed meat (7%). Plant-based meat products, venison, game/ hunted meat, and other meat types only make up a minor portion in participants' weekly diets (less than 2%).
Over the past year, nearly half of survey respondents (47%) lowered their meat consumption; most of them (69%) had consumed less meat overall while the rest of meat reducers (31%) only lowered the consumption of particular meat products.
When it came to motivations for reducing meat consumption, “lack of affordability and health concerns” are their key drivers.
Survey participants were also asked to indicate the top 3 factors or words that they considered important to define sustainability for meat production. The most frequent terms include animal welfare, environmental impact and grass-fed closely followed by carbon/ GHG emissions, “free range” and “farming methods”.
Although the respondents' awareness of alternative proteins or meat alternatives was high, their consumption of these products was rated as very low compared to what is reported in other countries.
AgResearch senior scientist Cameron Craigie says the headline survey result on omnivorous diets is not surprising given the value and tradition of meat eating in New Zealand.

“The survey is a snapshot in time, but for us as researchers, it does help us focus on the research that addresses the issues that people
care most about. Clearly taste is a key factor for meat eaters and that’s why we are doing research to help producers maximise that.”
The value or impacts of meat in a diet has recently been the subject of several reports internationally, including the Food and Agriculture Organization of the United Nations (FAO) stating that “meat, eggs and milk offer crucial sources of much-needed nutrients which cannot easily be obtained from plant-based foods”.
The full published research, including the survey findings and information, can be viewed here.
Newsbites
Cameron Craigie, AgResearch Scientist, was a member of the group studying New Zealanders' meat eating habits
Export opportunities in Asia


New research finds Asia’s growing demand for alternative proteins is an opportunity for Australian and New Zealand manufacturers to harness a new market.
China’s increasing interest in alternative proteins makes it the most favourable market prospect in Asia for exporters of plant-based meat and cellular agriculture products such as cultivated meat. The research is available in a new report called Alternative Proteins and Asia published by independent alternative proteins think tank, Food Frontier, which partnered with researchers Mintel and New Zealand’s food and fibre sector think tank Te Puna Whakaaronui to identify new export opportunities for manufacturers.
Alternative Proteins and Asia
Insights for Australian and New Zealand exporters on China, Singapore, South Korea, Japan and Thailand.

Researchers assessed 11 countries across Asia. The top five countries with the greatest market potential were identified as follows, listed in order of opportunity: China, Singapore, South Korea, Thailand and Japan. The report includes primary research from 5,000 consumers across these markets.


Food Frontier Executive Director, Dr Simon Eassom, says Australia and New Zealand have long traded with Asia, occupying a privileged position as close neighbours and reliable trading partners of safe and quality goods.
He says, “With an expanding alternative proteins market in Asia, Australia and New Zealand have the potential to build a major new food export industry that complements our existing ones.”
“Health, environmental and food security concerns are behind the growing demand for alternative proteins. Global demand for meat is likely to double by 2050, driven by population growth and prosperity, particularly in Asia.
“Consumer interest in healthy and environmentally sustainable protein options is increasing, leading to more people becoming
Factors driving the expansion of the Alternative Protein Ecosystem
ADM has released its outlook on what's driving the advancement of the protein ecosystem. The report details four factors driving the expansion of protein choices to feed the world’s growing population while keeping the planet’s best interest in mind.
“Creating a sustainable and secure food system that addresses the sensory experience, nutrition and accessibility is vital to supporting the needs of people around the world,” said Leticia Gonçalves, president, Global Foods, ADM. “We’re excited to share what we believe is needed to expand the protein ecosystem and encourage additional consumer acceptance and adoption.”
ADM has outlined what it will take to expand the alternative protein landscape while addressing concerns, demands, and gaps now and for generations to come:
• Anticipating the next wave of advancements
• Championing consumer adoption
• Bridging the gap to better nutrition
• Solving accessibility with a tailored approach
Learn more about the four driving factors and find a breakdown of consumer and market insights here.
interested in a flexitarian diet – one where they regularly swap conventional animal meat for new options like plant-based meat, which provides a familiar eating experience without compromising on nutritional value.
“Flexitarians are driving demand for alternative proteins in Australia – our latest research shows this is also the case in Asia. A quarter of Chinese identify as flexitarian and one third plan to reduce at least one type of meat. Similarly, twenty-six percent of South Koreans want to reduce meat consumption”

Food Frontier is the independent think tank on alternative proteins in Australia and New Zealand. Funded by grants and donations, our work is growing our region’s protein supply with new, sustainable and nutritious options that create value for businesses, farmers and consumers.
You can download the full report HERE.
Inaugural Grocery Commissioner appointed

“The appointment of the Grocery Commissioner is a momentous day for the sector as well as the wider retail environment,” says NZFGC Chief Executive Raewyn Bleakley, “By holding supermarkets to account, the Commissioner will help make a meaningful difference to competition and behaviour that shoppers and the sector so desperately want to see.”
“As a former long-time executive in the FMCG sector, including leading Sanitarium Health and Wellbeing and other companies, and being Chair of the New Zealand Food and Grocery Council, Pierre van Heerden will bring a deep understanding of the sector to this vital role.”
The New Zealand Food and Grocery Council welcomes the appointment of former grocery sector leader Pierre van Heerden as New Zealand’s inaugural Grocery Commissioner
We are looking forward to the Commissioner issuing guidance on aspects such as application of the good faith provisions, operation of the grace period provisions during transition, and arrangements around the grocery supply agreements supported by a strong and comprehensive Grocery Code of Conduct.
“The Food and Grocery Council looks forward to working with Mr van Heerden and his team, and retailers, to help deliver consumers optimum choice and price.”
Food New Zealand 6 Newsbites
v
Vertical farming systems build traction
A mechanised growing system with the potential to improve New Zealand’s food production security will be set up in Ashburton by the end of August, with planting to commence early September. It will be the first opportunity for New Zealand horticulturalists to see a full-sized Vertical Farm Systems XA Series (VFS) growing system in operation, courtesy of the New Zealand supplier, Landlogic.
The Ashburton set-up is a Landlogic initiative to showcase what a vertical food production system can do. VFS is a modular system designed for warehouse installation with plants grown in multilevel trays contained in climate and light-controlled cells.

Landlogic CEO, Alan Cottington, says the fully automated vertical growing system offers an important alternative to producing commercial levels of leafy greens in the horticultural industry, where traditional outdoor growing systems have taken such a huge hit in recent floods and storms.
“The increasing unpredictability and frequency of severe weather events, attributed to global warming, along with the rising costs impacting traditional open-field farming, mean it's more important than ever to consider new approaches to sustainable agriculture,” Cottington says. “Our food security is vulnerable when we rely on traditional farming methods or importation for leafy greens, which are a basic and healthy food essential.”
In agribusiness the commercial production of leafy greens, herbs or plant seedlings using multi-level growing systems is rapidly expanding around the world.
The VFS system is best suited to fast-growing crops, including leafy greens such as loose-leaf lettuce, baby spinach, arugula, mizuna, tatsoi, endive, pak choy, bok choy, beet chard, and herbs such as coriander, parsley, and basil.
There are no ‘seasonal crops’ and no crop losses. “Harvest times and end product quality are consistent and reliable, allowing commercial growers to confidently commit to delivery schedules and quantity agreements.”
In addition to helping with local food security, Cottington says the VFS system is better for the environment especially in such areas as water quality, fertiliser use and pest control chemicals.
Landlogic is the importer and distributor of Vertical Farm Systems for New Zealand and the Pacific, as well as sales agent for the rest of the world – except Canada, Scandinavia, Philippines and USA– and Cottington says vertical farming is a big opportunity for Pacific Island countries to combat growing concerns of food security and access to nutritional foods.

Newsbites
Vertical farming systems are increasingly important for food production security
Investigating nutritional properties of Microalgae
Cawthron Institute has teamed up with biotechnology nutrition startup, NewFish, and Nelson-based marine engineering firm, Kernohan Engineering to explore the nutritional properties of microalgae. The project will see around 100 strains of microalgae from Cawthron’s globally significant Culture Collection investigated for nutritional properties and ease of production that could open up new sustainable protein industries across Aotearoa New Zealand.
“The aim of this project is to identify the best microalgae strains, and then produce them at scale so they can be processed into alternative protein and other ingredients for functional foods,” said Cawthron Science Impact Manager, Dr Johan Svenson.
Cawthron Institute is home to a treasure trove of more than 600 species in their microalgae Culture Collection, so is potentially sitting on a lot of untapped opportunity.
“Cawthron has more than 30 years of algae research expertise, and during that time we have developed a cultivation method that can increase certain algae production, enabling efficient production and development here in Aotearoa New Zealand,” said Dr Svenson. NewFish CEO, Toby Lane, said that certain microalgae were known
Successful Fine Food New Zealand 2023
The recently concluded Fine Food New Zealand event attracted record numbers of exhibitors and delegates, contributing to an event that was not only a stunning success, but a litmus test for a resurgent hospitality industry determined to make the most of every available opportunity.

The three-day trade-only event took place in late June at the ASB Showgrounds in Auckland, drawing 6,405 unique attendees – an increase of 6.5% over the number of delegates who attended 2021’s event. In response to those numbers, event manager Deb Haimes says, “Fantastic result, we had 288 exhibitors offering the widest range of products, services, produce, innovations, and a ton more. The number of vendors was well up on the last event, and the combination of more to see delivered an amazing experience for every delegate.”
Exhibitors have expressed their satisfaction with Fine Food New Zealand 2023, too. Early feedback is universally positive, with vendors experiencing keen interest and strong demand for their products and services.
With any exhibition, the quality of delegates matters to exhibitors. Fine Food New Zealand is ‘trade-only’ by design, so only those in food service, hospitality, beverage, and related industries are in attendance. This consistently delivers the results vendors seek:
to be rich and complete nutrition sources for people, and are a sustainable, high-quality protein source that could signal the start of whole new protein sector.
“The nutritional credentials of some microalgae strains are on par with animal alternatives, yet the environmental impact is microscopic in comparison. The next step is to show the world how delicious microalgae is, so we’re working on a range of applications, starting with bars and drinks targeting active and sports nutrition markets.”
The advantage of microalgae is that it can be grown in bioreactors using a fraction of the resources that traditional food sources use without taking up natural or arable farmland. That’s where Kernohan Engineering expertise comes in, helping to develop production systems that enable the flexible and sustainable production of green protein for the future.
The Government is investing $750,000 in the $1.5 million project through the Ministry for Primary Industries’ Sustainable Food and Fibre Futures fund (SFF Futures), with NewFish and Kernohan contributing the balance.
Minister for Oceans and Fisheries, Rachel Brooking, announced the funding at Cawthron’s Algal Centre and said the Government is backing investigations into a potential new food industry for New Zealand.

expanding market reach, opening new avenues to market, and above all, driving sales of great products and services.
Haimes says the response to the event has surpassed expectations and the litmus test has come back with the right result. “It’s been a tough and truly unprecedented time for the industry. But Kiwi hospitality has shown its resilience once again, with the indomitable Kiwi spirit shining through. We’re looking forward to some productive years before we return in 2025.”
The next Fine Food New Zealand is scheduled for 29 June - 1 July 2025.
Food New Zealand 8 Newsbites
The Microalgae R&D team with Minister Rachel Brooking, third from right in front row
Rhodiola rosea raw material permits

Spain’s authorities have certified the entirety of Nektium’s Rhodiolife® Rhodiola rosea inventory as CITES-compliant.

The approval means the Las Palmas-based company now has permits in place to commercialise large volumes of Rhodiolife® for customers within the EU and worldwide, both directly and via its network of global distributors.
In February, CITES incorporated Rhodiola spp. into Appendix II, its list of endangered species that are subject to international trade controls. On 20 May, the EU added Rhodiola spp. to Annex B, its equivalent list of species subject to restrictions. Subsequent to this, Nektium applied for trade permits for its existing Rhodiolife® stocks. These were granted on 16 June.
CITES is the Convention on International Trade in Endangered Species of Flora and Fauna. Although a voluntary organisation, its decisions are considered binding for the 184 countries that are members.
Rhodiola rosea is one of nature’s most potent adaptogens, offering a range of scientifically proven cognitive health and sports performance benefits. The popularity of the plant, which grows wild in the remote Altai mountains in south and central Asia, has put pressure on supplies, leading to over-harvesting. Historically, Nektium has relied on wild Rhodiola rosea roots harvested using sustainable practices.
But the company recently pioneered the large-scale cultivation of Rhodiola rosea at levels sufficient to satisfy market demand. Based on the island of Gran Canaria, Spain, Nektium specialises in the supply of branded and generic botanical ingredients of the highest quality. In 1997, little was known about many of these botanical extracts, but the team at Nektium made it their mission to explore and unleash their potential health benefits.
Newsbites
Nektium has secured new CITES trade permits for Rhodiola rosea raw material
2023 International Symposium on cell-based food ingredients

Ben Sutherland, Principal Food Technologist | Standards & Surveillance, FSANZ

I recently attended an international symposium on cell-based food ingredients in Seoul, organised by the Korean Ministry of Food and Drug Safety (MFDS). The MFDS has been strengthening international cooperation and food safety dialogue in the Asia Pacific region to facilitate management of novel foods in line with global standards and extend support for industry exports through collaborative efforts.
I was joined by 5 regulators from other regions and it soon became clear there is general agreement amongst all of us that cell-based foods will be considered novel foods. All have a clear, established regulatory pathway for the approval of novel foods which can accommodate cell-based foods. Like a number of other food standards bodies, Food Standards Australia New Zealand may be setting standards for a number of these foods in the future so this commonality in approach is welcome.
William Hallman from Rutgers University gave a fascinating talk on risk communication strategies for safety management of novel foods. William noted that as cell-cultured meat, poultry and seafood products moved closer to markets in the USA and elsewhere, it is critical for stakeholders, including government, industry, academia, consumer organisations and the media, to adopt common nomenclature and risk communication strategies to help consumers understand these products and the technologies involved. William discussed key criteria for assessing appropriate labelling of these products, particularly the attributes and technologies that will influence perceptions of their risks, best practises for engaging with consumers, policymakers and other stakeholders, and the skillset required for communicating the risks.
Not surprisingly there was a call for harmonisation in risk assessment on a global level as each region requests the same data in assessing the safety of cell-based foods. The Godfather of cell-based foods, Professor Mark Post, noted we’re all looking at the same stuff, so how about some harmonisation in risk assessment? Clearly risk management strategies will be different across various regions, but there are synergies within risk assessment which could quite easily be shared.
Mark spoke on developmental strategies for cultivated meat in the EU, listing challenges as being technical, logistical and regulatory in nature. These included the use of “food-alien” proteins to replace serum, use of the cheapest possible food grade ingredients as opposed to pharmaceutical grade, and the reliance on cell division to create astronomical numbers of mammalian cells. Mark mentioned the need for “animal-component-free” culture of cells and tissues, abstinence from antibiotic use, and use of genetic modification as solutions available to developers of cultivated foods. Mark also noted that there are several initiatives being taken, such as work by the FAO and some NGOs and trade organisations to harmonise regulatory approval processes across the world. He said this is exactly what is needed as consumers are increasingly willing to accept alternative sources of meat, giving the sector an appreciable tailwind. The huge potential
for improvement and extension of applied tissue engineering for food makes this an exciting scientific and regulatory endeavour for the next couple of decades.
Watch this space!
In the Republic of Korea itself, several universities acknowledged the demand for alternative protein sources due to population growth, climate change, farmland shortages, declining biodiversity and an increase in informed consumers. Areas of research recognise the usefulness of microbial amino acids for supplementation of plant proteins and animal feed and a view that single cell derived novel food ingredients and haem could enhance the value of alternative proteins, provided their production is safely regulated. Recent advances in adaptive laboratory evolution in synthetic biology have enabled the development of new cell types as sources of novel food ingredients offering unique nutritional profiles and features such as colour flavour and textures. The development of novel foods from Korean native plants was also being investigated. I gathered there are around 10 start up cell-based meat companies in the Republic of Korea, many of which were present at the symposium.
While all of this is fascinating, it's our role as regulators to enable a clear regulatory pathway for the sector, one in which global food regulatory harmonisation should play a significant role.
Food New Zealand 10
Food Safety
Local delegates and international speakers in Seoul with Ben Sutherland, FSANZ, back right
NZ Food Safety News
Celebrating New Zealand’s Success at Codex: 60 years and beyond
In mid-June, New Zealand Food Safety and our wider organisation, the Ministry for Primary Industries (MPI), celebrated a significant milestone – the 60th anniversary of Codex, and 60 years of New Zealand’s successful engagement at the largest global forum for food standards.
Established in 1963, the Codex Alimentarius Commission (Codex –Latin for ‘food code’) is a joint food standards programme of the Food and Agriculture Organization of the United Nations and the World Health Organisation. The mission is simple: “safe, good food for everyone, everywhere”. With 189 member nations, and one member organisation (the European Union), Codex is the main global forum for international food standards, an important area for economic and health diplomacy for our country.
The celebratory event at Parliament on 20 June included speeches from Minister for Food Safety, Hon Rachel Brooking and Minister for Agriculture and for Trade and Export Growth, Hon Damien O’Connor, underscoring the importance New Zealand places on its engagement at Codex and highlighting our successes. Several organisations that have made a significant contribution to New Zealand’s Codex footprint were represented on the night, including Fonterra, the Meat Industry Association, Horticulture New Zealand, Zespri, the New Zealand Food & Grocery Council, Seafood NZ Ltd, and Olives New Zealand.
Short remarks made by Mike Cronin, Managing Director, Corporative Affairs, Fonterra, and Emma Glover, Executive Officer of Olives NZ noted the benefits of Codex standards to their businesses and industries, particularly in terms of market development and reduction of technical barriers to trade.
This video, launched at the event, highlights New Zealand’s contributions at Codex to date, and acknowledges Codex’s important role in protecting consumers and ensuring fair practices in food trade.
What does it mean for industry?
Led by MPI, New Zealand’s work with Codex (both at the headquarters in Rome, Italy, and at regional committees) has a material and positive impact on the whole food sector – from food businesses, manufacturers and importers, to the hospitality industry. We all know that food standards are vital for the health, wellbeing and prosperity of our people. Food standards mean safer food for consumers who can trust the food they are buying and eating – at home and internationally. New Zealand is a strong trading nation and food standards are good news for our exporters, meaning importers around the world can trust in the quality and safety of food they’re buying from New Zealand and that global markets trust New Zealand’s assurances.
New Zealand has played a leading role in Codex since its inception, with Kiwi, H. Doyle being one of three Vice-Chairs of the inaugural Commission. Now history has repeated itself as MPI’s Raj Rajasekar sits as one of the current three Vice-Chairs.

Through Codex, New Zealand has led the development of international standards around meat hygiene and milk and milk products. It has also served as host country for Codex Committees on these important areas and has played a leading role in the development of other international standards. This includes food hygiene, food additives,

pesticides and veterinary drug residues, food labelling, nutrition, food inspection and certification systems, fresh fruits and vegetables, and methods of analysis and sampling.
All of this directly benefits New Zealand producers, growers, manufacturers and the primary sector. A stronger food standards environment translates to stronger and more prosperous economic conditions, and safer food for all.
Looking ahead
Celebrations at Parliament closed with the launch of New Zealand’s Strategic Objectives in Codex 2022-2026, an outline for New Zealand’s continued role and work there. The objectives are to:
• Influence standards relevant to New Zealand’s food safety, human health protection, nutrition, and trade interests by actively participating in Codex.
• Ensure New Zealand’s regulatory systems are informed by and aligned with Codex.
• Promote a strong Codex system and advocate for global uptake and use of Codex standards, guidelines, and recommendations. A key area of the strategy relates to partnering with Māori/Iwi to understand their aspirations for international trade in food products and how this can be supported through Codex. MPI will also be looking to strengthen ties with key stakeholders and Codex members, including those in the South West Pacific region, to support development of standards, guidelines, and recommendations in areas of mutual interest.
New Zealand places considerable importance on our relationships, membership and active leadership and participation at Codex. As a country, we are well positioned to contribute new thinking and promote the development of international standards essential to advancing our trade and market access interests.
Sixty years on, Codex has demonstrated its immense value to international organisations, member-countries and global citizens alike, and we look forward to continuing our robust engagement on behalf of New Zealand exporters, food businesses, those in the primary sector, and our consumers – indeed all New Zealanders.
August / September 2023 11 Food Safety
MPI’s Raj Rajasekar has been appointed one of three ViceChairs of the Codex Commission. A New Zealander, H. Doyle, held the same position in the inaugural commission in 1963
Oils and Fats News
Laurence Eyres FNZIFST

A regular roundup of news and opinion from the Oils and Fats Group of the New Zealand Institute of Chemistry.
AAOCS Conference Newcastle
The 2023 Australasian section of the American Oil Chemists’ Society (AAOCS) conference is at Noah’s on the Beach in Newcastle Australia, Nov 13-15th 2023.
Extra benefits on offer
1. The first 50 people to register will receive an Omega-3 Index test kit valued at $59.95 each. Thanks to OmegaQuant, who are suppling 50 kits which measure levels of Omega-3 in your blood. Get in quick to get one HERE
2. For Students we are offering 2 x $500 travel bursaries to get to the conferences for people doing their PhD or MSc. Fantastic opportunity to display your work in a great environment and we will foot the bill. How to apply is HERE
3. The agendas for the two workshops are now available so please check them out at the links below.
a. Sustainable Ingredients for Food and Feeds HERE
b. Lipids in the health of our futures HERE
Contact Dr. Matt Miller: Matt.Miller@cawthron.org.nz
Shark Liver Oil (squalene)
Squalene and its hydrogenated product (squalane) are long chain hydrocarbons. Shark liver oil is the generic term to describe a mixture of squalene, diacylglyceryl (DAGE) ethers and triacylglycerol (TAG) derived from the livers of certain deep-water dogfish species. Squalene is the purified distillate from shark liver oil, having 99.85% active ingredient. Squalane is the fully hydrogenated product (no trans).
They are both used as dietary supplements and in skin products. For many years there have been cheap substitutes of low quality on the market which has ruined the businesses who focus on quality natural products.
Now Australian Standard (AS) 5380:2023 which has taken several years, has finally been published. It specifies requirements for the responsible harvesting of sustainable sources of squalene and shark
liver oil, quality parameters and methods for testing and analysis, and requirements for packaging and labelling consumer products, especially when claiming provenance.
Australian Standards are voluntary. They do not include contractual, legal or statutory requirements. This document does not replace the provisions of the Australian Fisheries Management Authority, Australia New Zealand Food Standards Code, Therapeutic Goods Administration or applicable Commonwealth, State and Territory laws and regulations.
Our well-known colleague and expert on marine oils, the main author on the standard, Dr Peter Nichols, has also just published a paper. Using Compound-Specific Carbon Stable Isotope Analysis of Squalene to Establish Provenance and Ensure Sustainability for the Deep-Water Shark Liver Oil Industry, Sustainability (July 2022)14(15):9228,DOI: 10.3390/su14159228
Squalene in Olive Oil
Modern Olives (Australia) have also looked at the provenance of olive oil and squalene content. We received a quotation from Claudia Guillaume as follows.
We have been testing squalene for several years at our groves (Australia and USA) and the range is quite maintained. I would say that the variation is more driven by Maturity index and variety than origin. In our main varieties the range of squalene is quite consistent over the years in both countries, as per below:
• Arbequina – 2600 – 3400 mg/kg
• Coratina – 4000 – 4500 mg/kg
• Picual – 6000 – 7000 mg/kg
Reference: Determination of fatty acid methyl esters (cis and trans) and squalene in olive oil and other vegetable oils by gas chromatography (2023): International Standard ISO 24363 For historical interest, an early reference to work done: Eyres, Laurence, et al. "Potential of squalene as a functional lipid in foods and cosmetics." Lipid Technology 12 (2002): 104-107.
Food New Zealand 12
Oils & Fats
Brain Lipids
“Loss of myelin sheaths occurs during the normal ageing process and in neurological diseases, such as multiple sclerosis and Alzheimer’s disease," said Sengottuvel Vetrivel, senior research fellow with DukeNUS’ Cardiovascular & Metabolic Disorders (CVMD) Programme and lead investigator of the study. "Developing therapies to improve myelination – the formation of the myelin sheath – in ageing and disease is of great importance to ease any difficulties caused by declining myelination."
Lipid Transporter
To pave the way for developing such therapies, the researchers sought to understand the role of Mfsd2a, a protein that transports Lysophosphatidylcholine (LPC) – a lipid that has an omega-3 fatty acid – into the brain as part of the myelination process. From what is known, genetic defects in the Mfsd2a gene leads to significantly reduced myelination and a birth defect called microcephaly, which causes the baby’s head to be much smaller than it should be.
In preclinical models, the team showed that removing Mfsd2a from precursor cells that mature into myelin-producing cells – known as oligodendrocytes – in the brain led to deficient myelination after birth. Further investigations, including single-cell RNA sequencing, showed that Mfsd2a’s absence caused the pool of fatty acid molecules – particularly omega-3 fats – to be reduced in the precursor cells, preventing these cells from maturing into oligodendrocytes.
"Our study indicates that LPC omega-3 lipids function as factors within the brain to direct oligodendrocyte development, a process that is critical for brain myelination," explained David Silver, senior author of the study and deputy director of the CVMD Programme. "This opens up potential avenues to develop therapies and dietary supplements based on LPC omega-3 lipids that might help.
Pentadecanoic acid-C15:0-A healthy saturate?
There are claims that dietary, odd-chain saturated fatty acids (OCFAs), especially C15:0, are active fatty acids, having cell-based activities and in vivo efficacy that align with health benefits, including lower risk of inflammation, cardiometabolic diseases, and NASH, to which they have been associated with some epidemiological studies in humans. Chronic low-grade inflammation, driven by proinflammatory chemokines and cytokines, contributes to cardiometabolic comorbidities and the ageing process 48–50. Saturated fatty acids have few health benefits compared to unsaturated fatty acids. Despite bold claims, the jury is still out. The company pushing dietary supplement called C15 make all sorts of health claims based on a zoologist’s work with dolphins. It is an expensive supplement.
A bottle costs $USD 119.95 for 90 days’ supply, NZD $2.20 per day.
Arnott’s biscuits reopening production in NZ

Arnott’s has opened a new factory in Avondale which it says will help it create biscuits designed for local palates “for the first time … in a long time”. For the first time in 25 years, Arnott’s will be producing in New Zealand again, after taking over Kiwi cracker business 180 Degrees and launching a new multi-million-dollar 4000sqm manufacturing facility and innovation hub.
The 4000 square-metre plant employs 40 people across manufacturing, three research and development staff and a health and safety team,
Arnott’s announced the decision to build the factory 12 months ago. It’s the first time it has brought manufacturing back to New Zealand in 25 years.
The plant has transferred staff and equipment from Kiwi cracker manufacturer, 180 Degrees' Glendene factory. “It will also further strengthen the century-long affection we know Kiwis have had for the Arnott’s brand, which recently saw us recognised as New Zealand’s most trusted biscuit brand in the 2023 Reader's Digest Annual Trusted Brand Awards.”
Many years ago, this author worked for the major oil company in New Zealand, Abels who supplied it with their range of fat products.
August / September 2023 13 Oils & Fats
Made in New Zealand again. Arnott’s have opened a 4000 square-metre factory in Avondale which it says will help it create biscuits designed for local palates for the first time in 25 years
2023 NZIFST Salary Survey
John Lawson, Lawson Williams Recruitment
Employer and employee salary expectations are misaligned
In my 30 years in the employment sector, I have never experienced a time like now where employers and employees have such varied expectations around what salaries can or should be paid in the Food Industry.
The 2023 Lawson Williams, NZIFST and NZFGC employer Salary Survey has been released and shows some interesting trends around salaries and benefits.

It is no surprise that we report significant increases in salaries since our last survey in 2021, well beyond the more typical 3% annual CPI increase.
(You can find out more by visiting www.lawsonwilliams.co.nz/ surveys)
We have all heard about the pressure on salaries over the past two years. Recent reports have suggested that 72% of employees are currently feeling underpaid in New Zealand with 42% saying they will actively negotiate their salary in 2023. Over 52% believe they will benefit from changing jobs. (Hays)

Yet we have also read recently that many organisations are attempting to budget only a 3% increase in salaries in 2023 and 2024 – despite the high level of inflation and increasing cost of living and despite the continuing and increasing demand for skills. (Mercer)

How can this be?
Well, it is true that the New Zealand economy is slowing and as a result many companies are becoming more cautious. The numbers of job adverts on job boards have decreased but surprisingly, they remain at higher levels than 2019 and the persistent low unemployment rate underpins the ongoing shortage of skills.
Immigration levels are up. Are companies expecting that this will alleviate the pressure on skills and salary increases?
The immigration data however shows that most of the current migrants are filling roles in the tourism, hospitality, construction and logistics sectors, not the highly skilled roles that the New Zealand Food Industry needs.
We are seeing significantly lower interest in New Zealand from skilled migrants than expected. It appears they have all gone somewhere else!
The 2023 Food Industry Salary Survey provides some interesting
insight.
Our survey has now grown to the size that we can show detailed data across location and company size among other variables.
When we look at the salary increases that have occurred against company size, the 2023 survey results present very clearly that the smaller the company the higher the percentage of salary increases since 2021.
Larger companies have more easily moderated the impact of the increases in salaries we have seen in 2021 and 2022.
Smaller companies have had to respond and increase salaries to higher levels to ensure attraction and retention of the skills they need. In future articles we will investigate these differences in more detail. What are large companies doing to respond to the changes in the employment market. What can employers regardless of size do to attract and retain staff.
Is it all about the money? The answer is no, but beware, it’s never been more important!
Food New Zealand 14 Careers
Specialist Recruitment - Permanent and Contract www.lawsonwilliams.co.nz
John Lawson is founder of Lawson Williams Consulting Group. He initially studied Biotechnology at Massey and is a professional member of NZIFST. He now enjoys leading a team of recruitment consultants, helping people like you develop satisfying careers.
Employees have their eyes on remuneration as never before!
J C Andrews Address 2023: John D Brooks
Keep flaming the loop
This award is in memory of Dr John Clark "Jack" Andrews who proposed the establishment of the Chair in Food Technology at the University of New Zealand in the 1960s. It is largely through him that we are all gathered here today.
I never met Jack, but I had tea with him every morning, as his portrait hung in the staff common room in the Riddett Building. It’s a great honour to be joining the previous recipients of this award. Dr. Garth Wallace was the first recipient – he helped me when I joined the Food Technology Department at Massey in 1977. Professor Mary Earle, who became my mentor, was also an awardee. “Come
on Brooks, get that PhD written.” Without her, I would never have completed the PhD write-up. My supervisor at Sydney University had abandoned five PhD students and I found it difficult to write up my work without supervision while writing lectures at Massey. When Wendy informed me of this award, she said the winner presents a keynote address on a topic of their choice at the NZIFST annual conference. Not an easy choice – Flying Gliders? Flying UAVs in Antarctica? Perhaps a lecture on food microbiology? Many of you will have already suffered my Food Micro lectures. Spoiler alert – you don’t get off scot-free. So, I’m going to pick out some aspects of my career – I have never worked in the food industry, but thinking back, it has always featured.

August / September 2023 15 J C Andrews
John Brooks, 2023 J C Andrews awardee, as many know him, seated at a microscope
Continuous change


First I’d like to discuss briefly the changes that have occurred in the food industry over the last 70 years. Initially, it was very simple, most production was exported. Now our food has a much greater variety, comes from many sources and the storage, packaging, transportation and distribution have become much more complex. Who would have thought that oats grown in New Zealand would be exported and processed into oak milk overseas and then imported back here? Even food produced and sold here is considerably more complex, and central distribution hubs mean that supply chains are longer. Our diet has changed – 70 years ago, meat might have been eaten three times a day, particularly in rural areas, but now much less meat is consumed and some of us rely largely on plant-based foods.
Consumer expectations have also changed dramatically – they want a wide variety of foods, either fresh or processed and, with perfect reason, they want the food to be safe. This has led to increased legislation and regulation, such as the requirement for HACCPbased food safety plans. This is a worldwide phenomenon. In some cases, it leads to strange consequences. In Arkansas farmers’ markets, you can buy Non-TCS Foods, defined as “food that does not require time or temperature control for safety to limit pathogenic microorganism growth or toxin production and as defined in the rules of the Department of Health”. “Uncut fresh fruits and vegetables” are explicitly named as falling under the non-TCS foods category. The rules named “Ready-to-eat foods” as foods that are covered under the non-TCS foods. “Any ready–to-eat food that is prepared on-site or any food that is provided to the consumer in a non-prepackaged form can only be sold or served from an ADH-permitted and inspected facility. Any establishment preparing, selling, or serving any of these food items must fully comply with the Arkansas Department of Health’s
Food New Zealand 16 J C Andrews
“Keep flaming the loop”, refers to one of earliest things a practical microbiologist learns. The inoculating loop is used to transfer microbial cultures from one medium to another. The loop is sterilised between transfers by passing it through a flame
Taking social distancing to extremes? In Antarctica in 2014
Rules and Regulations.” Therefore, a tomato is a non-TCS food, however, a cut tomato may be considered a ready-to-eat food, so if the seller shows traditional southern generosity and cuts the tomato and offers a taste to the consumer, they are in contravention of the regulations. A similar situation arose here some years ago with the shelling of walnuts in the orchard or under a simple shelter, which was required to comply with the rules for a processing facility. The requirements of our trading partners have also become more stringent.
Lately, gene editing, ‘lab-grown meat’, and insect consumption have become hot topics. I’m going to leave it there as these ideas potentially open up new cans of worms if you will.
Finally, I think that we need to take more notice of our food consumers. The questions I receive from readers of my food safety blog and my own observations suggest that many people still don’t understand how to avoid food poisoning, and we don’t teach young people the basics of food safety.
Connections
It occurred to me that my career was a reflection of James Burke’s TV series “Connections”. He demonstrated how various discoveries, scientific achievements, and historical world events were built from one another successively in an interconnected but unpredictable way to bring about particular aspects of modern technology. Of course, the inventor of an accurate escapement mechanism for a clock probably didn’t realise that this would lead to more precise ship navigation. Some of the material I was taught as an undergraduate seemed to
have no relevance for me, but 50 years later, I find myself applying it. I don’t believe in fate, but it does seem that stuff just comes together in unexpected ways.

Student days
My journey started at Queen Elizabeth College, University of London, with a so-called Special Microbiology Degree. The Head of Department was S. John Pirt and there were 24 undergraduates. There were courses in Physical Optics, Surface Chemistry, Organic and Inorganic Chemistry, Maths, Calculus, and Electronic Circuit Theory. Somewhere, there was one course on Introductory Microbiology, and two years later, one on food microbiology, which didn’t particularly impress me.
Pirt had been a microbiologist at Porton Down, a science and defence technology campus in England, and had written a seminal text, Principles of Microbe and Cell Cultivation. He introduced us to a controlled environment culture apparatus of his own design and we conducted an experiment to measure a growth curve and set up a steady state.
We attended Intercol, a short series of lectures at various London colleges, on thermophiles and their enzymes, Again, this became relevant only much later when we studied thermophiles in the New Zealand dairy industry.
John Norris, author of “Methods in Microbiology” from Shell Sittingbourne, Kent came in to give lectures and run practical classes, introducing the concept of Single Cell Protein (SCP). (Remember, this was in the 1960s.) He encouraged me to spend a summer holiday at Sandoz in Switzerland, working on tissue culture.
August / September 2023 17 J C Andrews
John’s happy place
Discontinuous growth of a pseudomonad

Unexpectedly, the cells in the fermenter were alternately in carbon excess and then starved, over a period of 170 seconds.
Commercial SCP production
Immediately on graduation, encouraged by Pirt, (I don’t think he wanted me in his PhD student programme) I went to ICI to work on the SCP process. The initial substrate was methane, but that can be exciting, as it is explosive with oxygen, so methanol was substituted. ICI had ready access to methane and owned the low-pressure catalytic process to make methanol. Because of the huge energy requirements to stir a culture vessel capable of making 50,000 tonne/yr of SCP, it was decided to use an air-lift fermenter. Because of some concerns with the “pressure cycle fermenter”, I was tasked with modelling this device, so developed a modification of a lab fermenter. (The pressure in the culture fluid varied from 1 to 6.5 atm over the circulation period).

What we didn’t expect was that the cells would alternately be in carbon excess and then starved, over a period of 170 seconds. I found that with increasing cycle time, the cell yield dropped dramatically and carbon dioxide production increased proportionally. (See Fig. 1) I showed that this was caused by the energy-wasteful shuttling of glutamine and glutamate in an attempt to readjust their enzyme and key intermediate levels. The end result was that the process was modified by injection of methanol and air in the downcomer to prevent cyclic starvation.
A PhD in Sydney
After being told that I had reached my career maximum at age 24, I left ICI and went to Sydney to do a PhD, still working on C1
Food New Zealand 18 J C Andrews
0 50 100 150 200
Yield (g/g methanol) 0.45 0.40 0.35
time (s)
Fig. 1 The yeilds of bacteria (l) and carbon dioxide (s) when both methanol and nutrient salts were added intermittently to continuosly growing Pseudomonas mythylotropha
Cycle
The enormous ICI production fermenter being installed. The fermenter was 60m tall with a capacity of 3,000m3
metabolism, with a grant from ICI. I studied the determinants of yield and attempted to find a predictive measure. This turned out to be the number of electrons available for oxidation in the substrate molecule. I wanted to find the number of sites of oxidative phosphorylation in the cells and grew them on methanol, formaldehyde and formic acid, the sequence of oxidation in the cell. Thus, I have the dubious honour of being the first person in the world successfully to grow bacteria in steady-state on formaldehyde. The basis for this came from a study of Pirt’s book – in steady-state, the residual concentration of substrate is practically zero. This study can’t be done in shake flask culture.
…and on to New Zealand
After the PhD, I couldn’t get a job in Australia – nobody wanted a fermentation engineer at that time, and the prospect of making paper bags or canning kangaroos for pet food didn’t appeal. I applied for and got the job of Lecturer in Food Microbiology at Massey University. I arrived in New Zealand on a Wednesday and gave my first lecture on the following Tuesday. I was terrified. I had 13 students in my class and they were only six years younger than I.
I stayed there for 30 years and perhaps my greatest achievement was to teach food microbiology to 940 undergraduates and some hundreds of Dairy Diploma students. I get great satisfaction from seeing those graduates in senior positions in the New Zealand and overseas food industries. Later, I spent a year teaching at Hong Kong University, where I had 360 undergraduates, and eventually was appointed Professor of Food Microbiology at AUT, where I developed and taught a course “Frontiers of Food Microbiology to 180 postgraduates.
At Massey, I was greatly influenced by a paper by A.N. Sharpe “Germ of a New Food Microbiology” in which he claimed that the true tragedy of agar is that it stimulated the development of a whole science around a unique type of analysis – The Plate Count. By its nature, it provides data so unique that they can be related to no other analytical data than those from other plate counts. Problems include whether the bacteria clumped, how vigorously the dilutions are prepared, whether they are viable but non-culturable or sublethally injured and whether they can grow on selective media. I studied many different automated analytical techniques that could speed up analysis and potentially provide more information on the microbiological safety and stability of foods, predominantly based on activity, but to this day, our microbiological specifications for food are still given in terms of plate counts. The number of specific bacterial cells in the food at point of production takes no account of handling in the supermarket or home. Will the numbers increase to hazardous levels or will they produce toxins? What we really need is to be able to show whether the food will spoil or become hazardous to the consumer and this requires dose-response data. Of course, we have no simple laboratory method of determining viruses in foods.
The biofilm project

Another major event occurred when Steve Flint came into my office in 1996 and asked if I knew anyone who could supervise a PhD on biofilms. I suggested that we could learn together He was at that time employed by the Dairy Research Institute and this gave us access to the industry. We joined with Dr. Phil Bremer and spent about 15 years studying thermophilic biofilms in dairy plants.
Sitting in a meeting of people from NZ Dairy Board, I heard that
“Thermophilic bacilli do not form biofilms in milk evaporation and drying plant.” I didn’t believe this, as the residence time in the plant is too short for growth to occur in the flowing milk to the level seen in the finished powder. A calculation on the back of an airline ticket showed that thermophilic bacilli must form biofilms in the plant, growing and shedding both cells and spores into the flowing milk. Very quickly, we were able to show that vegetative cells and even spores can attach to 316 stainless steel in less than 60 seconds and become very difficult to remove fairly soon afterwards. Attachment is a multivariate process and depends on the suspending medium, the substrate's physical characteristics, whether it is clean or dirty, and the bacterial cells' surface. Lifschits-van der Waals forces, hydrogen bonds and electrostatic charge and the production of extracellular polymeric materials are all involved.
Steve and I were able to establish a biofilm research unit at Massey, with support from the “Plant Availability Project” of NZDB. We studied the attachment and growth of thermophiles and thermodurics and also the use of temperature cycling suggested by Geoff Knight in Australia. Our post-doctoral fellow, Shanthi Parkar studied cleaning methods specifically with respect to the materials of construction. We were ultimately able to work for a short time in a brand-new milk powder plant at Clandeboye and suggest minor modifications to the process.
Old microbiologists never stop working
Of course, all good things come to an end and I decided to retire. Initially, I panicked – “What am I going to do all day?” However, I have been a consultant to about 50 companies having problems with microbial contamination here and in Australia and I continue this work. Most recently, I went back to first principles (Thanks Pirt) to show that a shipment of frozen product to China must have been temperature-abused for 145 to 180 hours at one of two different temperatures prior to shipping. There is no software app that can do that. I am lucky to remain in contact with Steve Flint and am called upon to assess Food Technology student HACCP projects. Eventually, I began to wonder how I ever found time to go to work.
I guess old microbiologists never stop working, they just become more cultured.
August / September 2023 19 J C Andrews
Biofilm of Streptococcus on 316 stainless steel

Food New Zealand 20

August / September 2023 21
Foodtech Packtech 2023: Unveiling the Future of Food Innovation
Mark your calendars for Foodtech Packtech featuring the Materials Handling & Logistics Expo, the ultimate trade showcase for the food and beverage manufacturing and logistics industries. From packaging and food processing equipment to ingredients, food safety, and sustainability, this event promises to be a game-changer for your business. Held at the Auckland Showgrounds, the floorplan is almost full to capacity, making this the largest trade show for over a decade and an unmissable event for the entire industry.
A notable highlight is the return of international exhibitors for the first time since the pandemic, bringing with them cutting-edge technologies and advancements from around the globe. With over 225 exhibitors participating, attendees will have ample opportunities to explore new technologies and meet new suppliers. Industry giants like Vemag, Oji Fibre Solutions, Motion NZ, TNA, Heat & Control, Food Processing Equipment (FPE) and Mettler Toledo will be present, unveiling their latest breakthroughs, including meat processing equipment, food-grade hydraulic presses, flexible packaging options, food processing equipment and precision weighing instruments –and that's just the tip of the iceberg.


One of the most exciting features of this year's event is "The Pantry," a new food ingredients area. Developed based on valuable visitor feedback, it promises to be a unique experience that delves into the latest trends in the industry, including plant-based food ingredient alternatives. Exhibitors such as ICMD, Formula Foods, and Carmi Flavours will be on hand to showcase their innovations, while Reward Hospitality will create a sensory experience by using these ingredients in their onsite commercial kitchen, allowing attendees to see, taste, and smell the featured ingredients.
Beyond the exhibition of new technologies and products, the event aims to foster learning and collaboration among industry peers. The three jam-packed days of seminars will cover all categories represented at the show, providing an immersive platform for attendees to stay up-to-date with the latest advancements in food technology and to collaborate on solutions that will shape the future of the industry. The event offers an excellent opportunity for professionals to come together, network, and develop ideas that will future-proof their businesses. The presence of strategic partners further cements the
importance of innovation in the industry. Callaghan Innovation will be on hand to offer various services, including funding, research and development, and innovation expertise. The New Zealand Institute of Food Science and Technology will again host dedicated seminars, supporting the education and development of the food industry.
Packaging is a critical aspect of the food and manufacturing industries, and this event doesn't fall short in that regard. Exhibitors like Sealed Air, Prime Pac, Packtech Moulding and Forbes Packaging will display cutting-edge packaging solutions designed to enhance the shelf life of various food products. Add to this more automation and robotics on display than ever before. You are guaranteed to find something new! Foodtech Packtech featuring the Materials Handling & Logistics Expo is scheduled for 19-21 September at the Auckland Showgrounds. With the support of strategic partners and being the largest trade show in over a decade, it is an event not to be missed.
Attendance is entirely free. Register to attend for FREE at www. foodtechpacktech.co.nz or www.mhlexpo.co.nz
Food New Zealand 22 Exhibition

Formula Foods
Innovating natural flavours and ingredients at New Zealand's flavour house company. Formula Foods, the renowned Flavour House company based in Christchurch, continues to make waves in the food industry with their innovative offerings. From spice and herb oleoresins, natural antioxidants to spray-dried flavours, they have established themselves as a go-to supplier for natural, high-quality ingredients. In this article, we'll explore some of their latest developments and how they are meeting the changing demands of consumers.
Expanding expertise
With the recent acquisition of Scios Ltd, Formula Foods has expanded their expertise in the supply of base ingredients and client-specific blends. This move allows them to offer a comprehensive savoury range of natural oleoresin extracts and natural antioxidants, that provide consistent flavour, aroma, colour, and shelf-life enhancement for prepared foods and food ingredients. This acquisition further

solidifies Formula Foods' position as a leading player in the industry. Formula Foods is proud to announce the production of their range of spray-dried powder Flavours in Christchurch. These flavours are natural, high-quality ingredients that can be used in various applications. The advantage of local production allows for greater customisation, ensuring that clients can develop or adjust flavour profiles to meet their customers' evolving preferences, making them a popular choice among food manufacturers.
Introducing Eggxel
One of the company's standout ingredients is Eggxel, a colour-free powder that serves as an excellent part-replacement for eggs in bakery products. By combining milk proteins with eggs, Eggxel offers a cost-effective solution without compromising the finished product's quality. With its ability to bind water and improve shelf life, Eggxel presents an attractive option for bakers looking to reduce costs without sacrificing taste or texture.
Meeting consumer trends
Formula Foods understands the importance of staying ahead of consumer trends. To cater to the desire for unique and exciting flavours, they have developed a wide range of exotic options. Among their favourites are Yuzu, a citrus fruit known for its bitter taste and popularity in beverages; Blood Orange, a bittersweet citrus with raspberry undertones; Lychee, a sweet and delicate flavour often found in desserts and beverages and Taro, which offers a slightly nutty and earthy note, making it a versatile choice for both sweet and savoury dishes.
Formula Foods, New Zealand's Flavour House company, continues to make strides in the food industry with their innovative products. From their extensive range of spice and herb oleoresins and natural antioxidants to their customisable spray-dried powder Flavours, they are committed to meeting the demands of their clients and consumers alike. By staying attuned to market trends and developing unique flavour profiles, Formula Foods remains at the forefront of providing natural, high-quality ingredients to the ever-evolving food industry. See them at Stand 150, The Pantry Food Ingredients Feature
TNA New Zealand
Visitors to stand 3102 at FoodTech PackTech 2023 will have the opportunity to experience the pioneering tna robag® 3e and the tna intelli-flav® OMS 5.1 first hand, as well as to speak with local experts directly about TNA’s customer-centric approach to complete line solutions and how the company is leveraging the very latest VR capabilities.
From potato chips, nuts and seeds and pretzels, to meat based snacks, popcorn and ethnic/traditional products, our experts will be on hand to walk visitors through the process of creating tailor made solutions to individual challenges, and to offer live demonstrations of the latest technical innovations for the snacks market.
The ‘Perfect Pair’ adds significant value to complete integrated lines. This powerful combination features the tna robag® 3e – a high-speed vertical form fill and seal (VFFS) packaging system capable of reaching
Food New Zealand 24 FTPT
speeds of up to 250 bags per minute, along with the tna auto-splice 3, which seamlessly splices packaging film without interrupting the packaging process, maximising throughput and enabling faster and smoother film changeovers. These advances in packaging technology help manufacturers to optimise resource usage, simplify servicing, improve diagnostics and achieve operational efficiencies, resulting in more efficient and sustainable packaging operations.

The tna intelli-flav® OMS 5.1 is the next-generation on-machine seasoning (OMS) system that provides both powder flavouring and liquid oil in a single drum. It ensures consistent and precise seasoning coverage for a variety of snacks, including fried, puffed, and baked products. The system utilises a mass-based gravimetric spraying and dry seasoning control method, weighing the raw materials to apply the exact amount of seasoning or oil required based on a preprogrammed recipe.
TNA provides comprehensive, complete-line solutions designed for the highest output, minimal downtime and reduced total cost of ownership. TNA’s extensive offer covers every aspect of food processing and packaging

FTPT
The pioneering tna robag® 3e
Look out for the
Energy efficient food processing solutions
HRS Heat Exchangers, Stand 2110

HRS Heat Exchangers is set to showcase its market-leading food processing solutions, designed to help manufacturers improve energy efficiency and reduce operating costs, at this year’s Foodtech Packtech. Part of the global EIL Group, HRS Heat Exchangers has more than four decades of experience, helping businesses to reduce energy consumption in all areas of food production such as pasteurisation and sterilisation. Today, as manufacturers continue to face the dual challenge of high energy costs and the need to reduce carbon, it is essential for every business to examine the equipment it uses and identify where immediate savings and longer-term efficiencies can be made.
Chris Little, managing director, HRS Australia & New Zealand said: “Delivering unparalleled energy efficiency, HRS Heat Exchangers solutions provide the shortest possible payback period and rapid return on investment.”
“A difference of 5-10% in thermal efficiency, for instance, will quickly translate into direct savings in energy and operating costs while rising wholesale energy prices could see the payback period reduced further still.
to learn more about their products for the food and drink industry
“HRS equipment includes hygienic corrugated tube and scrapedsurface heat exchanger designs which are ideally suited to highly viscous products, improving heat transfer and operational efficiency. At the same time, options such as heat regeneration provide the highest levels of energy efficiency which cuts costs and reduces carbon. Features such as remote monitoring and telemetry are standard.” Offering stand-alone solutions or complete packaged systems, HRS produces a wide range of equipment as well as bespoke systems, including:
• Corrugated tube and scraped surface heat exchangers
• Pasteurisers and sterilisers
• In-Place Cleaning systems (CIP & SIP)
• Aseptic fillers
• Direct steam injection sterilisers
• Concentration and evaporation systems
• Ice crushers and melters
• Hydraulic piston pumps
• Air removal (deaeration) systems
Food New Zealand 26 FTPT
distinctive orange shoes worn by the HRS team,
Specific solutions for products and packaging
You will find them at Wadding Solutions
When searching for the right packaging components, it always helps to have a solid understanding of your options. This is especially true with closure liners, where their performance is key to preventing leakage and loss of product quality. It can be a challenge to navigate their differences and design details, but at Wadding Solutions our packaging experts will guide you and find the right solutions for your products.
There are many different types of closure liners, along with various types of caps that utilise them. Closure linings are there to provide a hermetic seal, demonstrate product integrity through the use of a tamper-evident seal, and prevent leakage.


We recommend talking through your product’s need for a seal, we also encourage customers to trial and validate various lining options with their products and packaging. At Wadding Solutions we can assist you with testing your products in our food grade certified facility. We have a vast tooling library and range of sealing equipment.
Overall, closure lining enhances product integrity, ensures consumer safety, and presents an opportunity for companies to deliver a higher quality, more reliable product experience.
Our friendly team is here ready to assist you, whether you need help with your packaging design, specific requests or simply want to learn
more about the services our business can offer, reaching out to us is an excellent next step. We are committed to providing exceptional customer service so your enquiry and feedback are invaluable to us.
FTPT
Wadding Solutions supplies specific solutions for products and packaging
Cuddon Freeze Dry’s new ‘green’ commercial conductive batch freeze dryer

Cuddon Freeze Dry
Cuddon Freeze Dry are delighted to announce the launch of our new ‘green’ range of commercial conductive batch freeze dryers. Designed with reduced whole of life costs and reduced environmental footprint from the outset, we are incredibly proud to be leading the field in this technology.
With the global movement to replace synthetic refrigerant gases with more environmentally acceptable alternates (driven by the Montreal Protocol and updated by the Paris Agreement 2015), the new range of Cuddon freeze dryers has been specifically
designed, built and optimized for CO2 refrigerant; there is no compromise on performance often associated with dropin alternate refrigerants. The range matches or exceeds the performance of the previous Cuddon R507 general purpose freeze dryers.
We will also be offering a retro-fit package to enable our current clients to switch to CO2 refrigerant. Released earlier this year, there are 3 options: from a simple switch out of refrigeration machinery through to a full upgrade to the higher capacity shelf area, ice coil and CO2 refrigerant.
Food New Zealand 28 FTPT
AIP events at FTPT
AIP will offer a packaging forum and a training course alongside Foodtech PackTech 2023.
After an extended hiatus due to the pandemic, the AIP will be back in person hosting an extensive range of educational programmes alongside FoodTech PackTech 2023. The AIP educational offerings include a full day of Packaging Sessions, a training course and an AIP stand where you can visit the education team.
Packaging Forum – 19th September
Upstairs seminar room, 10.30 am to 4.30 pm
The sessions will be designed as panel discussions covering a broad range of topics including packaging targets, waste directives, Sustainable & Circular packaging innovations and designs, incorporating recycled content into packaging, the future of soft plastics and flexible packaging, how to embed the 10 Sustainable Packaging Design Principles into your business, the role that packaging plays in minimising food waste, the future of fibre and renewable materials, the important role that the Australasian Recycling Labelling programme plays across ANZ and updates for ANZPAC. The speakers will also include a number of NZ winners of the ANZ PIDA Awards and the WorldStar Packaging Awards. Just some of the speakers confirmed this far…
• Lyn Mayes, Sustainability Lead, NZ Food & Grocery Council
• Liz Butcher, Manager Waste Streams Policy, Ministry for the Environment New Zealand
• Nerida Kelton FAIP, Executive Director – AIP, VP Sustainability & Save Food WPO
• Nikki Withington MAIP, NZ Co-ordinator – ARL & the ANZPAC Plastics Pact, APCO
• Kitty Sandoval MAIP, Senior Packaging Manager, Frucor Suntory Oceania
• Sarah Yanez MAIP, CPP, Director, Totally Wrapt Packaging
• Huzaifa Mohsinally MAIP, Packaging Manager, Goodman Fielder New Zealand
• Ben McCulloch AAIP, Product Manager (rPET), Martogg
• Deanne Holdsworth, General Manager Sales, Pact Packaging NZ, Pact Group
• Alan Adams MAIP, Sustainability Director APAC, SEE
• Joe Foster FAIP, Chief Executive Officer, Close the Loop Group
• Vikas Ahuja, Sustainability Director, Tetra Pak
• Barbara Nebel, Chief Executive Officer, thinkstep-anz
• Chris Thomas, Divisional Manager Packaging, BJ Ball NZ Ltd
• Apoorv Mehrotra AAIP, Business Development Manager, Oji Fibre Solutions
• Florian Graichen, General Manager – Forests to Biobased Products, Scion
Flexible Packaging: Now and Into the Future Training Course, 20th September.
10.00 am for a 10.30 am start
The Flexible Packaging: Now & Into the Future training course will cover the basic fundamentals of flexible packaging, its benefits, how you chose the specific structures to match the product, its performance, marketing challenges and how the packaging is manufactured. The course will discuss the options, pros and cons of Compostability vs Recyclability, moves to mono material recyclable packaging to meet CEFLEX standards and other innovative alternative materials now available. As an add on, the course will be looking at the future plans for flexible packaging and available closed loop collection programs, kerbside collection development, advanced recycling options for circular design and many others to meet Packaging and Food Waste Targets.
The objectives of the course are to give participants knowledge of:
• The benefits of Flexible packaging.
• The process of manufacturing.
• Where the future lies with flexible films and the changes ahead.
• A snapshot of some of the latest packaging trends and what are the driving forces.
• The challenges facing us with the sustainable packaging race toward sustainability.
The course is aimed at Packaging Technologists and Designers, Product developers, marketing personal, technical and production staff using packaging, sales and marketing reps who want a crash course on all things ‘Flexible’.
LECTURER: Joe Foster FAIP,
AIP Education Team
As the Chief Executive Officer of the Global company Close the Loop Group Joe has been heavily involved in the flexible packaging industry for over 35 years with experience in engineering, production, technical, sales and marketing. He has a truly global view of the flexible packaging world having started his career in Ireland and worked in Zimbabwe, South Africa and Australia. Joe has was recognised by the AIP as Industry Packaging Professional of the Year and the WPO with a Lifetime Achievement Award.
All AIP training courses are internationally recognised and approved to attain Certified Packaging Professional (CPP) points towards the global designation.
AIP Stand – Stand 160 in Hall 1
As the peak professional body for packaging training and education in Australasia for the last 60 years please come and visit the AIP on stand 160 and find out how the Institute can help you and your teams to become highly skilled packaging professionals and technologists. The AIP are here to help answer any question regarding packaging, sustainable and circular packaging design, the Australasian Recycling Labelling Program, the Sustainable Packaging Design.

August / September 2023 29
FTPT
NZFSSRC Food Safety Symposium Wrap
This article has been written exclusively for FoodNZ by the NZ Food Safety Science & Research Centre.
There was a lucky break in the snowstorm as a plane-load of food safety luminaries nervously prepared to land in Dunedin. They had been repeatedly warned on departure to expect to turn back to Wellington (and not to expect Air NZ to pay for accommodation). That break in the weather meant that the NZFSSRC annual symposium, physically delayed three years by COVID-19, was finally able to proceed with all but two speakers arriving in time.
A year (and more) in review – and onwards
The Symposium ranged in topic from a landscape-size, multigeneration project led by iwi, supported by the Centre and partners, to restore the health of tuna/eels in Whakakī Lake (near Wairoa) – to the wicked problem Denver McGregor (NZ King Salmon) had rooting out a persistent Listeria population from the floor of a processing facility. He made this whole-genome-sequencing exemplar as engaging as a Netflix murder mystery.
Denver ultimately proved more persistent than the Listeria , and won the 2021 Significant Contribution to Food Safety Award for his ‘above and beyond the call of duty’ efforts to maintain the highest possible food safety standards at NZ King Salmon. This year, the NZFS Award went to recently-retired Dr Rob Lake, who has been a key member of the Centre’s Science Leadership Team, and a very important link between the Centre and ESR. Rob chaired the session on food safety priorities.
Welcome from the Centre Director
In her welcome address, Centre Director Libby Harrison recalled the case of her fellow zoology student who had nearly died of salmonellosis on a field trip to India – invoking unpleasant OE memories among many of what is sure to happen when you break the cardinal rules of not consuming salads or iced drinks when travelling in places with less rigorous food safety regulations. Now, she heads an organisation with an estimated worth to New Zealand of $164M a year by insuring our gold standard reputation for safe food. That dollar figure is the bottom line of a just-released study by Lincoln University’s Agricultural Economic Research Unit and makes the government contribution of $2.5M with matching funds from industry, a pretty good deal.
A Cook’s tour
A Cook’s-tour of NZ Food Safety priorities by Roger Cook (Acting Director Food Science & Risk Assessment at New Zealand Food Safety) emphasised how many things they are dealing with currently. He barely made it through his longlist:
• STECs (more types of STEC O157 are proliferating) are a market access priority
• Attention to the Māori agri-sector
• Tahini and salmonellosis
NZFSSRC Women in Science Breakfast – a warming start
On the Monday morning, committed women delegates made their way pre-dawn across the freezing wet courtyard of the Otago University campus to attend the women’s breakfast, and hear personal experiences of imposter syndrome. Chair Anne Astin and her panel members, who all seemed to be unlikely sufferers, albeit now mostly recovered, introduced delegates to various self-help therapies, including the Japanese concept of wabi sabi – in art translated as the ‘beauty of flaws’. In other words, women should stop the self-defeating, punishing drive for perfection, instead of accepting that they “are enough”. Summing up, Astin quoted Michelle Obama who assures women in her autobiography that having met most of the top blokes in world government, they need have no fears of inadequacy. But this was certainly no man-hating session – panel members gave full credit to the male colleagues who had helped and encouraged them to achieve and succeed, including going for that elusive promotion.
• Listeria management for small industries; genetic technologies – we need to know which genes trigger toxin production as opposed to species
• Hep A – there’s higher risk with the dietary popularity of berry smoothies
• Lead in sugar
• Mercury in fish
• Are microplastics a problem for humans?
• Mycotoxins
• Chicken packs without soaker panels, resulting in water splashing everywhere when you rinse the plastic containers
• Nutrition safety – sugar, salt and fat
– and last but not least, contributing to FSANZ’s review of infant formula.
Effective chairing and timekeeping
No exceptions were made, however, to MC Glen Neal’s strict timekeeping regime, which meant that the nigh-impossible was achieved – a programme that kept to time.
Glen’s leavening good humour was clearly appreciated by RNZ National presenter Kim Hill, who sat through the whole day’s programme taking copious notes in preparation for the evening event
Food New Zealand 30
NZFSSRC
Kim Hill facilitated the “Is science making our food safer?” discussion at the end of the Symposium. Panel members included, left to right, Sirma Karapeeva, MIA, Glen Neal, FSANZ, Kim Hill, Phil Bremer, NZFSSRC Chief Scientist, Jocelyn Eason, Plant & Food Research, Peter Cressey, ESR
she was to chair – a panel discussion entitled “Is science making our food safer?”

Who knew?
Who knew that food safety science could be so entertaining? The panel members (Phil Bremer, Sirma Karapeeva, Glen Neal, Jocelyn Eason, and Peter Cressey) were very well prepared to answer the question in the affirmative, and were relaxed under interrogation. All answered an unequivocal ‘yes’ to the proposition that we should revisit the regulations on GM/gene editing, and that food from any country of origin should be acceptable, IF safe and ethically produced. The audience, which included members of the public, did not all agree. If you were not lucky enough to be there, listen to it on the RNZ website here.
The food safety bar goes up and up
Centre board member Farzana Adams gave a rundown of industry food safety priorities. The food safety regulation bar just keeps on rising, as the sensitivity of chemical and pathogen detection keeps improving. Any new MRL (maximum residue limit) imposed on fresh produce could cost the industry around $10million to fulfil export requirements. She said industry were very nervous about food safety during the first two or three years of the pandemic, but the Centre gave them the scientific evidence to demonstrate to overseas buyers that our food was safe – a perfect example of how government, science and industry can work together for mutual benefit. Farzana gave ESR a pat on the back for doing such a good job on COVID-19 generally. With the prospect of gene editing opening up, Farzana noted that a current FSANZ assessment for a disease-resistant banana could be the first whole food to be approved for genetic modification in Australia and New Zealand.
Emerging scientists
The nine 3-minute presentations by emerging scientists were wellreceived, and did a good job of keeping people conscious after lunch. There was a double-take by the audience when University of Otago PhD student, Andrea Warburton, reported above-regulation amounts of toxic 2,3 butanedione and 2,3 pentanedione in half the vaping mixes she tested. The potential harm of vaping has been much in the news lately, and Andrea’s findings seemed significant.
Emillie Passfield from the Cawthron Institute was judged the winner for her clear and lively presentation on water quality measuring devices, developed for use onsite at the aforementioned Whakakī Lake. The locals need to know when algal toxins exceed safe levels so they can warn people not to harvest the eels, which can accumulate the poison in their flesh. Cawthron’s contribution to this project has been considerable. Emillie and the representative iwi sent to present the project earlier in the day – Trevor Waikawa Jnr – impressed delegates with the capability of the next generation to embrace science and take on the huge challenges of land restoration management. Members of the Centre’s consulting group, Te Tira Whakamana, led by the venerable Rauru Kirikiri, were there in force, showing their real involvement in the Centre’s mission. “We are not just a token advisory group sitting off to one side,” Rauru emphasised.
The judges of the emerging scientist competition were Tonkin & Taylor environmental consultant, Andrew Pearson, and Arnoud van Vliet and Leon Gorris, all members of the Centre International Science Advisory Panel, who travelled to New Zealand for the Symposium and thus expanded its field of view to Europe. Arnoud also contributed to the session: Is whole genome sequencing living up to the hype?
August / September 2023 31 NZFSSRC
A close look at Listeria
Another international contributor was Kathy Glass, Food Research Institute, UW-Madison, Wisconsin, who presented ‘An update on Listeria: emerging threats and control methods’, which, along with the other presentations, are available at www.nzfssrc.org.nz. This presentation is worth a close study by those continually trying to manage this risk. (Just after the Symposium a recall of raw milk was announced on the RNZ news bulletin). Kathy says the main takeout from her presentation is that while listeriosis is relatively rare, there will be a continued increase in the proportion of susceptible consumers we need to protect, that is older people.
She warned, “Every time we think we understand what foods are of greatest risk, there are surprises, such as fresh produce and frozen foods, so we need to be vigilant. Listeria is an insidious bug which we must battle constantly. It is important to teach consumers proper food handling so they can be partners in the food safety continuum.”
Still more big issues
No 2023 programme would have been complete without addressing the three big issues of our time – climate change, mis/disinformation and its able accomplice, AI. Climate change is now too big, broad and all-encompassing to be siloed into a single session, but environmental sustainability, as it applies to food safety, was the focus of a panel chaired by Centre Deputy Director, Tim Harwood. Food producers are treading a fine line between consumer pressure for the use of reusable, recyclable or compostable packaging, and increased food safety risks and food waste. Miranda Mirosa (University of Otago) reported that the latest estimate of food loss and waste globally is an astounding 40% – at sad odds with the rising price of food, serious food insecurity, and the admirable efforts by so many to rescue and redistribute food.
Stefan Stewart, food safety manager for horticultural producer LeaderBrand, recounted the company’s experience following Cyclone Gabrielle. He said they were literally trying to keep their head above water in Gisborne. Ironically, there was a water shortage crisis because Gisborne’s town water supply was not available to industry for several weeks. LeaderBrand were able to continue processing their salad greens, and also help other food and wine producers, by trucking in clean water from their new dam.
Brett Cowan, ESR’s Chief Scientist, has made an in-depth study of mis/disinformation. He questioned Fauci’s statement that “science is truth”. The power of science is its methodology, says Brett. Rather than being a collection of immutable facts, it demands flexible minds and responses to rapidly update our thinking as new evidence emerges. We’ve heard a lot of frightening projections of the harm AI could cause, but Daniel Xu from Element X talked about its promising potential to detect and classify bacteria and predict food spoilage –and how to approach investment in new AI technologies.

Lain Jager sums it up
Although he was first to present at the symposium – following the new Minister for Food Safety, Hon Rachel Brooking, who opened the meeting and set the scene admirably by outlining the food safety challenges facing New Zealand industry – we end our wrap up with the wide angle lens provided by Lain Jager (former Zespri CEO, past Chair of the Primary Sector Council, and co-Chair of Te Puna Whakaaronui). He identified the big drivers of change that are
stimulating the food system and driving investment in novel foods, precision agriculture, and cellular agriculture – climate change of course, uncertain geopolitics, and the forecast 40% climb in protein demand by 2050.
An aging demographic will put extraordinary pressure on economies and labour markets, and technology mean significant disruption globally, with AI predicted by Goldman Sac’s to impact 300million white collar jobs.
Lain identified strategies that are working – or at least showing signs of promise, such as the joint venture between industry and government to reduce methane emissions, though our investment in industrial policy to double electricity generation and grow food and fibre exports, while decarbonising the sector, is inadequate, he says. New Zealand’s competitor farmers and growers are much more impacted by climate change and other stresses than we are, but we do not compare well with other small economies with respect to R&D investment and business sophistication, and struggle culturally to do things at scale. New Zealand needs to double its renewable electricity in a very short time, but then we could become energy independent. We also need to develop the ‘blue economy’, he said.
Centre director Libby Harrison said delegates “well and truly got their money’s worth in big ideas, new information and sheer entertainment. And it was great to be all together again. That collegiality, and the friendships built over many years, are so important. ”
Food New Zealand 32 NZFSSRC
Lain Jager, co-Chair of Te Puna Whakaaronui, applied a wideangle lens to the big drivers of change in our food systems
EQI, an assay for measuring bioactivity of bovine whey proteins
Katharine Adam1, Grant Smolenski2, Colin Ogle1, Rodney Claycomb1
Affiliation: Quantec Ltd1, MS3 Solutions2
Introduction
There are a number of products on the market that contain bioactive whey proteins extracted from milk. These may contain single proteins, such as lactoferrin or immunoglobulins such as IgG, or a range of proteins, such as IDP® (Immune Defence Proteins), which contain 50 plus bioactive proteins. Some of the individual proteins, like lactoferrin, have been well studied, and claims have been made about them, including antibacterial, antiviral, and anti-inflammatory properties (Wang et al., 2019), while little is known about others. At present there is no method for identifying and measuring the bioactivity of cows’ milk protein products. The benefits of a standardised testing and reporting method for a bioactive natural product or ingredient can be seen with the introduction of UMF (Unique Manuka Factor) to the honey industry. The inclusion of a UMF score on Manuka honey packaging has allowed customers to easily assess the quality and activity of the product they are purchasing. A premium can be charged for products with high UMF scores, and incorrect or fraudulent claims can be identified though testing. Similar benefits could be gained from a testing method that assesses bioactivity of cows’ milk proteins.
Considerations
Cows’ milk naturally contains bioactive whey proteins produced by the cow to protect both the udder and the calf consuming the milk. The extraction and formulation process can alter the structure and functionality of the proteins resulting in varying levels of bioactivity. One area of interest is the difference between spray dried and freeze dried products (Morel et al., 2021). Exposing the proteins to heat during manufacture of final products can reduce the bioactivity of proteins through denaturation. As a result, the proteins in the final product may have little or no activity. Additionally, in final product formulations containing bioactive whey proteins, interaction between other non-milk based ingredients can occur, so care must also be taken with formulation considerations in order to retain bioactivity. Where multiple bioactive whey proteins are present, bioactivity may be a result of several mechanisms. For example, lactoferrin deprives bacteria of iron by chelating it and interacts with the cell membrane of some bacteria causing lysis (Conesa et al., 2008; García-Montoya et al., 2012; González-Chávez et al., 2009). Another mechanism is the lactoperoxidase system, that produces hypothiocyanite which inhibits bacterial glycolysis, respiration, and glucose transport (Bafort et al., 2014). Identifying the mechanism(s) responsible for bioactivity
becomes more complicated when multiple proteins are present. Also, simple quantification of a specific protein may not predict a specific level of activity in a sample as these may have been altered during the extraction and formulation process. The ratio and amount of each protein present in a finished product will also influence the activity.
Project scope
To determine the content and bioactivity of whey proteins and whey protein containing dietary supplement products, we designed EQI®, a three-part assay. The method combines multiple reaction monitoring (MRM) liquid chromatography-tandem mass spectrometry (LC-MS/MS), spectrophotometric rate determination of lactoperoxidase activity, and a minimum inhibitory concentration assay, to characterise the bioactivity. The first part of the method determines the presence and concentration of six specific dairy proteins: lactoferrin (Lf), lactoperoxidase (Lp), Immunoglobulin G1 (IgG), lysosomal alpha-mannosidase (LAM), angiogenin (ANG), and ribonuclease-4 (RNase4). This part essentially defines and verifies that the sample is indeed bioactive whey protein(s). The second part of the method measures the activity of a single protein, lactoperoxidase. This test uses a singular protein, lactoperoxidase, to gauge whether any bioactivity has been retained. Lactoperoxidase is sensitive to heat and its activity and is a good indicator that the sample has not been exposed to conditions that would have an adverse effect on bioactivity. Finally, to assess and quantify the actual level of bioactivity, the level

August / September 2023 33 Research
Figure 1. Example of EQI score registered trademark
solution was prepared by dissolving a 10 mg ABTS tablet into 5mL assay buffer. Dilute hydrogen peroxide solution was prepared by diluting 37.1 microlitres of 27% peroxide to 10mL with purified water.
Research
of antibacterial activity is tested and, from this, the bioactivity rating is determined.
For each sample an enzyme suspension was prepared. For wholly protein ingredients, 100mg samples were dissolved with vortexing in 10 ml of enzyme diluent. Dilutions of 1:2500-1:1000 were prepared in enzyme diluent for analysis. For dietary supplement products, 1g samples were dissolved with vortexing in 10ml of enzyme diluent. Dilutions of 1:250-1:100 were prepared in enzyme diluent for analysis.
A range of protein isolates and product formulations were tested using the assay. Results indicate that bioactivity of milk derived proteins varies, and that bioactivity, determined by antibacterial activity, is not correlated to the presence of a single protein.
Experimental
Materials
samples were dissolved with vortexing in 10ml of enzyme diluent. Dilutions of 1:250-1:100 were prepared in enzyme diluent for analysis.
For each test the following reagents were pipetted into a 1cm low absorbing plastic cuvette: Assay buffer 876.7µl, enzyme extract 33.3µl and ABTS solution 83.3µl. The cuvette was placed in a spectrometer with a thermocouple probe to monitor and measure the equilibrium temperature (T1). Hydrogen peroxide solution 6.7µl was mixed in and the initial rate DA/minute) at 420 nm was measured for 60-150s. Activity was calculated using the following formulae:
Active bovine whey protein ingredients: IDP and 96% pure freeze dried lactoferrin were sourced from manufacturers (Bega, Quantec). IDP is produced from milk. The milk is defatted and then proteins with an isoelectric point higher than 6.8 were collected using cationic chromatography. The resulting elution was concentrated by ultrafiltration and desalted. The protein concentrates were combined with whole milk powder (12.5%), dextrose (2%), monk fruit powder (0.4%) and skim milk powder (remainder), to produce examples of dietary supplement products.
Methods
Protein identification and quantification
For each test the following reagents were pipetted into a 1cm low absorbing plastic cuvette: Assay buffer 876.7µl, enzyme extract 33.3µl and ABTS solution 83.3µl. The cuvette was placed in a spectrometer with a thermocouple probe to monitor and measure the equilibrium temperature (T1). Hydrogen peroxide solution 6.7µl was mixed in and the initial rate (v, ∆A/minute) at 420 nm was measured for 60150s. Activity was calculated using the following formulae:
Df = Dilution factor (dilution of enzyme);
Df = Dilution factor (dilution of enzyme); 36 = mM extinction coefficient of oxidized ABTS at 420 nm<superscript>1; 0.0333 = Volume (in ml) of enzyme used.
Comprehensive identification of IDP proteins was performed using a ‘bottom-up’ LC-MS/MS approach. The IDP protein samples were digested with trypsin, following which the peptide mixtures were separated using reverse-phase high-performance liquid chromatography and analysed in-line by a high-resolution mass spectrometer, such as an Orbitrap Q-Exactive (ThermoFisher). The most abundant precursor ions in a given spectrum were then selected and fragmented into MS/MS for further analysis. Using bioinformatic software, each MS/MS spectrum (corresponding to a specific peptide sequence) was used to search a bovine-specific protein database to identify the proteins in each sample.
36 = mM extinction coefficient of oxidized ABTS at 420 nm1; 0.0333 = Volume (in ml) of enzyme used.
Determination of antibacterial properties
<colour>Determination of antibacterial properties
To measure the levels of six specific proteins (Lf, Lp, IgG, LAM, ANG, and Rnase4), a multiple reaction monitoring (MRM) approach was used. MRM is a mass spectrometry method based on the selection of a peptide ion and one or more characteristic fragment ions. Utilising stable isotope-labeled internal standard peptides, absolute quantitation (AQUA) was achieved. The synthetic internal standard peptide precisely mimics a peptide produced during proteolysis of the target protein, except that it is present in a known number of stable isotopes. Analysis of the enzyme-digested sample by an MRM experiment in a tandem mass spectrometer results in the direct detection and quantification of both the native peptide and a spiked amount of the isotope labelled internal standard peptide. The ratio of these two peptides is compared to the ratio of a peptide calibration curve made up of known concentrations of labelled and unlabelled peptide. The method was validated by conducting spiking studies of purified proteins and comparing them directly to ELISA assays.
Lactoperoxidase activity quantification
Assay buffer (phosphate buffer) was prepared by weighing 1.36g potassium dihydrogen phosphate and dissolving into 100mL water and adjusting to pH5.4 with 1M sodium hydroxide solution. Enzyme diluent was prepared by combining 40mL of pH5.4 phosphate buffer, 0.25g of bovine serum albumin, and 0.5mL of Triton X-100, and 55mL of purified water. ABTS solution was prepared by dissolving a 10 mg ABTS tablet into 5mL assay buffer. Dilute hydrogen peroxide solution was prepared by diluting 37.1 microlitres of 27% peroxide to 10mL with purified water.
For each sample an enzyme suspension was prepared. For wholly protein ingredients, 100mg samples were dissolved with vortexing in 10 ml of enzyme diluent. Dilutions of 1:2500-1:1000 were prepared in enzyme diluent for analysis. For dietary supplement products, 1g
Prepared microbiological media was obtained from Fort Richard laboratories (New Zealand). Bacillus subtilis subsp. Spizizenii NZRM 766 was obtained from the NZRM culture collection. It was revived in tryptic soy broth (TSB), streaked to a TSA slope, and maintained on Cryobeads at -80ºC (ThermoFisher Scientific, New Zealand). For wholly protein ingredients, 250mg samples were suspended in 10ml of TSB by heating to 40ºC for 20min. Glucose oxidase was added to give a concentration of 0.005mg/ml. Each sample was diluted to 2.5mg/ml and seven halving dilutions were prepared and dispensed into 96 well plates in 50µl aliquots in triplicate. For dietary supplement products, samples were prepared by dissolving half the labelled daily dose in 10ml of TSB by heating at 40ºC for 20min. Glucose oxidase was added to give a final concentration of 0.0005mg/ml. Samples were centrifuged at 35000g for 10 minutes and the supernatant filtered through a 0.45µm syringe driven filter. The initial sample and seven halving dilutions were dispensed into a 96 well plate in 50µl aliquots in triplicate. The wells were inoculated with a 5 hour broth culture of B. subtilis NZRM 766 giving a final concentration of between 150 and 500 cfu/well. Sodium thiocyanate solution, giving a final concentration of 40µg/ml, and a final volume of 100µl was added to each well. The plates were incubated at 37ºC for 12h and the OD600 was measured every 20min following 1min of shaking. The procedure was repeated three times. Each sample was given a score based on the reduction of growth at eight concentrations (OD600 at 12 hours minus OD600 at 20 minutes). The score was inverted so greater level of inhibition gave a higher score.
Determining the final score
Antibacterial activity can be the result of ingredients other than cows’ milk proteins. To avoid samples receiving a score based on this, the presence of specific proteins from step 1 of the test method are taken into account. The score determined by the antibacterial testing is multiplied by 1 or 0 based on the presence of lactoferrin, lactoperoxidase, and IgG. If at least one of the following is present: lactoferrin at ≥0.1mg/g, lactoperoxidase at ≥0.01mg/g, or IgG at ≥0.1mg/g the score is multiplied by 1. Statistical analysis was done in Microsoft Excel.
Results
The results of protein and product testing are shown in Table 1. The concentration of the individual proteins in IDP varied as evidenced by the standard deviations.
Food New Zealand 34
albumin, and 0.5mL of Triton X 100, and 55mL of purified water. ABTS
�������������������� �������� = (����!"#! ����$%&'( ) ∗ �������� 36 ∗ 0 0333
Table 1. Lactoperoxidase and antimicrobial activity of protein ingredients and products
Lf = lactoferrin, Lp = lactoperoxidase, IDP = Immune Defense Proteins, LAM = lysosomal alpha-mannosidase, ANG = angiogenin. The means and standard deviations shown are of the IDP samples.
Correlations between the individual proteins in the IDP samples and the score were calculated. The correlation between lactoperoxidase activity and lactoperoxidase concentration was also calculated. These are shown in Table 2. The correlation between lactoferrin, lactoperoxidase, and IgG and the EQI score was weak. The correlation between LAM, ANG, and RNase4 was very weak or non-existent. There was a moderate correlation between the lactoperoxidase concentration and the lactoperoxidase activity.
Discussion
We were able to successfully test all of the samples using the three part EQI assay. The concentration of proteins tested for using the LC-MS/MS method varied between types of sample and individual samples. The concentration of the proteins in the IDP containing products is consistent with the amount of IDP added to each sample. As expected, low levels of the proteins were detected in the no IDP product. These are present in the milk powder used in the formulation. The lactoperoxidase was not active in the product containing no IDP. The lack of a clear correlation between the EQI score and the concentration of any of the six proteins quantified indicates that bioactivity of IDP derives from the interactions of multiple proteins rather than a single protein.
Products containing three different concentrations of IDP were tested. The increase in concentration of IDP appears to have a linear relationship with the Lp activity, although testing a wider range of concentrations is necessary for statistical conformation. The concentration of IDP in finished product does not appear to have a linear relationship with EQI score. This is to be expected given the use of halving dilutions in the method. Again, further testing at more unique concentrations is required to confirm the relationship.
The product that did not contain IDP had no Lp activity, but an EQI score of 19. This indicates that the activity is due to something other than the Lp. This is likely to be the glucose oxidase, included to ensure the lactoperoxidase system is active. As such, an EQI score of less than 20 should not be considered an indicator of inherent bioactivity of the bioactive whey proteins. The intention is to include an EQI score on packaging indicating a minimum level of bioactivity, for example, 40+, 50+ etc. as shown in Figure 1.
It should be noted that, for this work, step 3 of the method was specific for antimicrobial or inhibitory bioactivity. Given that bioactive whey
Lf = lactoferrin, Lp = lactoperoxidase, IDP = Immune Defence Proteins, LAM = lysosomal alpha-mannosidase, ANG = angiogenin
proteins have a range of bioactivities, for which finished product claims can be based, it is envisioned that the EQI method may be adapted over time for specific bioactivities other than antimicrobial, such as anti-inflammatory or antiviral, or perhaps even adapted to quantify specific bioactive outcomes such as immune enhancement. In addition, step 1 of the method can be adapted to quantify additional bioactive whey proteins other than the six reported on in this work.
References
Bafort, F., Parisi, O., Perraudin, J. P., & Jijakli, M. H. (2014). Mode of Action of Lactoperoxidase as Related to Its Antimicrobial Activity: A Review. Enzyme Research, 2014, 1-13. https://doi.org/10.1155/2014/517164
Conesa, C., Sánchez, L., Rota, C., Pérez, M. D., Calvo, M., Farnaud, S., & Evans, R. W. (2008). Isolation of lactoferrin from milk of different species: calorimetric and antimicrobial studies. Comp Biochem Physiol B Biochem Mol Biol, 150(1), 131-139. https://doi.org/10.1016/j.cbpb.2008.02.005
García-Montoya, I. A., Cendón, T. S., Arévalo-Gallegos, S., & Rascón-Cruz, Q. (2012). Lactoferrin a multiple bioactive protein: An overview. Biochimica et Biophysica Acta (BBA) - General Subjects, 1820(3), 226-236. https://doi. org/10.1016/j.bbagen.2011.06.018
González-Chávez, S. A., Arévalo-Gallegos, S., & Rascón-Cruz, Q. (2009). Lactoferrin: structure, function and applications. Int J Antimicrob Agents, 33(4), 301.e301-308. https://doi.org/10.1016/j.ijantimicag.2008.07.020
Morel, J., Md Zain, S. N., & Archer, R. (2021). Comparison of drying techniques for bovine lactoferrin: Iron binding and antimicrobial properties of dried lactoferrin. International Dairy Journal, 105142. https://doi.org/https://doi.org/10.1016/j. idairyj.2021.105142
Wang, B., Timilsena, Y. P., Blanch, E., & Adhikari, B. (2019). Lactoferrin: Structure, function, denaturation and digestion. Critical Reviews in Food Science and Nutrition, 59(4), 580-596. https://doi.org/10.1080/10408398.2017.1381583
August / September 2023 35 Research
Lp U/mg Lp U/g EQI score Lf mg/g of sample Lp mg/g of sample IgG mg/g of sample LAM mg/g of sample ANG mg/g of sample RNase4 mg/g of sample Product 10% IDP 8985 77 56.09 26.07 15.25 0.029 1.694 1.413 Product 2.5% IDP 2489 59 16.8 6.9 7.96 0.012 0.482 0.365 Product no IDP 0 19 1.5 0.27 4.64 0.005 0.077 0.053 Lf 0 26 654.7 0.2 1.4 0.4 1.3 1.1 Lp 247 54 42.16 783.9 60.79 0.197 24.31 12.278 IDP A 100 57 573.4 240.3 45.4 1.31 109.3 42.81 IDP B 78 61 482.31 212.48 103.23 0.38 59.83 28.58 IDP C 134 63 474.98 391.41 56.12 1.278 151.363 64.828 IDP D 120 68 470.51 418.04 60.481 1.349 156.11 66.772 IDP E 87 66 365.83 389.51 60.58 1.194 154.698 71.674 IDP F 95 73 517.3 291.59 94.65 0.58 46.94 23.82 Mean (IDP) 480.7 323.9 70.1 1.0 113.0 49.7 Standard deviation (IDP) 68.2 87.4 23.2 0.4 49.5 20.8
Activity Protein concentration Correlation (r) r2 EQI Lf -0.31 0.09 EQI Lp 0.44 0.19 EQI IgG 0.39 0.15 EQI LAM -0.22 0.05 EQI ANG -0.14 0.02 EQI RNase4 -0.04 0.00 Lp Lp 0.65 0.42
Table 2. Correlations calculated using Pearson coefficient (r) and r2 values of protein concentrations versus activity
NZIFST News
NZIFST Directory
EXECUTIVE MANAGER Wendy Bayliss PO Box 44322, Pt Chevalier Auckland 1022 New Zealand
Phone: 022 549 8483, Email: wendy@nzifst.org.nz
PRESIDENT Esraa El Shall esraaelshall@gmail.com
VICE PRESIDENT Bob Olayo bob@matt.nz
TREASURER Grant Boston grant@boston.net.nz
Strategy Refresh
Over the last two years the NZIFST Executive, led by our new President Esraa El Shall, have worked through extensive project to refresh the vision of NZIFST, looking for strategies to help the Institute grow and remain relevant through an engaged membership that gets real value for being a part of us.
The team defined 5 areas of study.
• Membership: How do we engage with our current membership base?
• Financial: How do we ensure real benefits for our members?
• Partnerships: How do we have strategic partnerships that bring benefits to our members?
• Image: How do we remain relevant in our branding and communications?
• Growth: How do we grow our membership base?
Each question was investigated by a team of board members, leading to the graphic above.
The team has defined workstreams and is asking for volunteers to progress the work. More information is on the NZIFST website, including contacts for volunteers. https://www.nzifst.org.nz
(scroll down the homepage)

Food New Zealand 36
NZ IFST News
NZIFST AGM 2023
New President and Executive
At the NZIFST AGM, Returning Officer, Wendy Bayliss, announced the results of elections for members of the NZIFST Executive. The previous term's Vice-President has stepped into the Presidential role and a new Vice-President and a new Executive member were confirmed. Congratulations to all.
Our Executive members are:
President: Esraa El Shall
Vice-President: Bob Olayo
Immediate Past President: Phil Bremer
Honorary Treasurer: Grant Boston
Elected Executive Members
Paulette Elliot
Hamish Conway
Allan Main
President: Esraa El Shall
Esraa is Head of R&D at Fonterra Brands. She has been an active and committed member of the NZIFST over the past 12 years. She has taken varying roles, starting with the Auckland Branch as a Student Rep, then Branch Secretary, Vice Chair and Chair. While Vice-Chair and Chair she was Auckland Branch Representative on the Board and promoted a social media strategy for the Institute, so that we now have coordinated, active, national social media Facebook and LinkedIn pages. Phase two of the social media strategy continues to build on the foundation work that has already been done and amplify our messaging by shining a spotlight on the work that the Branches and the Institute do as well as the people behind all the great work.

Whilst Vice-President Esraa began work with the Executive on an extensive project to refresh the vision of NZIFST, redefine its Mission and develop a strategy to strengthen the Institute’s position in our industry and increase its relevance to members in the 21st Century. See page 36 for more information on this project.

Esraa recognises the important role NZIFST has had in her career and wants to make sure that all young professionals have the same opportunities as she had and will have the same passion for the future preservation of the NZIFST.
Bob Olayo: Vice-President
Throughout my many years as a dedicated member of the NZIFST, I have actively contributed to its growth and development. I have served as the Chair for both the Canterbury and Westland branches, held positions as a committee member, and served as an elected member of the Executive.
Additionally, I have the privilege of being part of a four-person team responsible for revising our institute's mission and vision. This undertaking has resulted in the implementation of crucial strategies, with me taking the lead in the area of membership and networking.
For more than 15 years, I have collaborated with a team of experts at Mätt Solutions and Formula Foods to provide food ingredients, high-quality services, and innovative solutions to leading food manufacturers, prestigious research institutions, and esteemed educational organisations in New Zealand. Throughout this time, I have been fortunate enough to deliver seminars on Water Activity, conduct comprehensive moisture courses, facilitate FIT courses for NZIFST, contribute to FF MAP seminars, NZFSPG events, and participate in Foodtech Packtech Seminars.
My extensive international training in the United States, Germany, Denmark, Australia, and Sweden has endowed me with invaluable experience and knowledge. I am eager to apply these insights to assist the food industry in tackling intriguing scientific, developmental, and manufacturing challenges.
I believe that I can offer operational experience and directorship level guidance to the board and institute to realize its vision and mission. However, I recognize that we face challenges that need to be addressed in the next 3-5 years. One of these challenges is membership. We also need to address the issue of value. To attract and retain members, we need to offer value and answer the question, "why should I become or continue to be a member of NZIFST?"
Finally, engagement is critical for retaining and attracting new members.
I am committed to addressing these challenges and working with the board and members to ensure that the NZIFST remains “A supportive and networked community driving a vibrant and sustainable food industry”.
August / September 2023 37 NZ IFST News
Grant Boston: Honorary Treasurer
After graduating BSc Hons in biochemistry
Grant Boston started his working life at the Christchurch Medical School, assisting in research on iron free radical metabolism with Christine Winterbourn, winner of the 2011 Rutherford Medal. He then moved to the Auckland School of Pharmacology to investigate adenosine metabolism.
In 1985 he moved to the NZ Dairy Research Institute, firstly in analytical chemistry and then in the milkfat and butter section where work followed on fat chemistry through thermodynamics to rheology. Grant was at NZDRI when Fonterra was formed and was made redundant due to restructuring as Fonterra Research developed. From 2006 he worked on contract for Fonterra Brands and Dairy Insight until 2007 when he joined NZPork as Research and Innovation Manager. Five and a half years later he joined OSPRI, the operator of the TBfree and NAIT programmes.


Grant recently joined the Regulatory Systems Policy directorate at the Ministry for Primary Industries as a Principal Adviser.

Elected Member of Executive:
Hamish Conway
Hamish is married with two young adult daughters plus a cat and dog and lives in Auckland. He has built a career in the food industry across a number of different roles, products and companies and is passionate about the opportunities for others to build a career in the food industry and the importance of the food industry to New Zealand's economic success.
That is where NZIFST, as the professional body for the food industry, plays a vital role tby encouraging people to enter the industry and providing its members with opportunities to connect, network, share knowledge, learn and grow together. This is done through the hard work and volunteered time of its members, especially those actively involved in the branches and at the national level.
I welcome the opportunity to continue my involvement on the Executive and build on the great work that has been done by many before me over many years to ensure that NZIFST continues to be a vibrant community for the food industry for the next 50 years.
Elected Member of Executive: Paulette Elliott

The executive committee have been working to refresh the vision, mission and strategy for NZIFST and begun planning the workstreams, work which I'm looking forward to continuing being involved in.
I have been a member of NZIFST since 2001, serving on the Canterbury branch committee for more than a decade across all roles including Chair, helping to organise our annual conferences
as a committee member several times and chairing the Conference in Christchurch in 2019. I was granted Fellowship in 2015.
I have worked across sectors in the New Zealand food industry, driven by a passion to help grow our exports, solve problems and convert ideas into reality. I currently work in the KPMG Propagate team, a specialist food and fibre advisory group.
I have a strong and lasting connection with NZIFST and I welcome the opportunity to continue to help lead and support the institute. As a proud Fellow I believe we can continue to develop the institute for the benefit of members and New Zealand, and I know I can bring my energy, ideas and perspectives to enable this transformation.
Elected Member of Executive:
Allan Main
Throughout my career I have enjoyed a close relationship with NZIFST, initially with the Wellington Branch, including helping to organise the 1992 annual conference “Capital Fare”, then on return from overseas with the Manawatu Branch and subsequently Central Branch committee. Through that association
I have been the Food New Zealand Central Branch correspondent continuously since 2013. At the 2021 NZIFST Conference I was awarded the Distinguished Service Award for Leadership in the Dairy Industry and Management of Intellectual Property.
I graduated B.Tech (Food Tech) with the class of 1975 and since then have had an extensive career at the interface of food technology and food markets through food industry innovation. About half of my food industry tenure has been in dairy industry innovation (R&D, technology transfer, technology strategy, business development and IP management) with the balance spanning a significant crosssection of food industry sectors (consumer products, functional food ingredients, brewing, most recently horticultural produce). A highlight of my time in the dairy industry was the five years I spent in Pennsylvania as Technical Manager for a New Zealand Dairy Board cheese technology acquisition leading the commercialisation of a proprietary value-add flavour technology. I also spent 10 years as a sole operator in IP Management consulting to a range of food and primary industry clients as MAINly Consulting.
I have recently retired from my current position as Business Manager (Food Innovation) at Plant & Food Research and so will have discretionary time to invest in furthering our Food Science and Technology profession. I believe that my extensive experience and diverse expertise will assist the orderly development of our institute and our profession. I look forward to being of service to all food professionals in that role.
Food New Zealand 38 NZ IFST News
New Members
NZIFST welcomes the following new members. Welcome also to new student and Graduate members
New Members
Courtney Adams
Lily Beachen
John Blankley
Quality/ R&D
Key Account Manager
Business Unit Manager - Food|Health|Nutrition
Anna Burnett Applications Technologist
Emma Byrne
Jannel Cedicol
Technical Account Manager
Quality control officer
Anna Cressy (nee Westrupp) Food Technologist
Rhonda Fraser
Chelsea Johnson
Duy Le
Philippa Millar
Charlotte Minson
Kevin Parish
Justine Paulin
Shannon Rees
Stacey Skelton
Dion Vincent
Sara Walden
Renyu Zhang
NewGraduateMembers
Senior Research Technologist
Applications Technologist
Process Technologist
Senior technologist
Food Safety and Quality Internal Audit Manager
General Manager
Quality Compliance Coordinator
Advisor - ERAS (Export Regulatory Advice Service)
Innovation Project Manager
Account & Business Development Manager
Specifications Technologist Scientist
Sensient Technologies
DKSH Performance Materials New Zealand Ltd
Chemiplas (NZ) Ltd
Invita NZ
GS Hall
Meadow Mushrooms Ltd
Honey New Zealand
Fonterra
Invita NZ Ltd
Sensient Technologies
J H Whittaker and Sons ltd
Fonterra
WNZ
Barker Fruit Processors Ltd
MPI
Westland Milk Products
Multivac
Prolife Foods
AgResearch Ltd
Fangzhi Jian Applications Technologist Hawkins Watts New Zealand
Nancy Ling Food Technician FoodSouth
Emilly Kaisean Chin Junior R&D Technologist Blue River Dairy LP
New Student Members
Lincoln University, Xi Gong
Massey University, Yongkyoung An, Kelly Hooton, Mingze Li, Ana Carolina Marshall, Sharmaine McLarin, Ruth Parkes, GeorgiaPerilli, Megan Ross, Anneliese Sinclair, Hannah Spencer, Emma Stewart, Sarah Wong, Cindy Zhu
University of Auckland, Minyue Guo, Dinesha Hansamali Perera, Katugampala Appuhamilage, Qimou Li, Xintong Xu, Maggie Zhou, Kangning Li, Murou Li, Yijun Liu, Yilin Liu, Zade Mahdi, Saifei Pang, Sarah Sherlock, Hui Ru Tan, Pei Wang
University of Canterbury, Sophia Gross
University of Otago, Joey Chen, Duyuan Cheng, Lucy Clark, Renzie Ege, Rizwan Matloob Ellahi, Faiqa Fatima, Taskeen Fatima, Lilli Fawcett, Wills Griffiths, Thilanka Haththotuwa, Ari Hayati, Sophie Haycock, Courtney Irwin, Grace Lewin, Xingcheng Li, Lara Milne, Kim Shanks, Lydia Sue, Louise Yadav, Inchara Yoganarasimhaswamy
August / September 2023 39 NZ IFST News
NZIFST Awards
The NZIFST Awards are presented every year at the Conference Dinner. This year the venerable and impressive Dunedin Town Hall Concert Hall was the venue for members to recognise the achievements of members.
J C Andrews Award: John D Brooks
This Award, the Institute’s most prestigious, is presented annually in memory of Massey University’s first Chancellor, Dr Jack Clark Andrews, who proposed that a food technology degree course be established at Massey University.
The award recognises Institute members who have made a substantial contribution to science and technology in the food industry.
We are pleased to honour a man whose name is synonymous with Food Safety in New Zealand. This reflects his expertise gained through almost 50 years of working in the food industry as a consultant and academic.

He has an impressive CV.
John gained his BSc (Hons) in microbiology at Queen Elizabeth College, London followed by a PhD in Biochemical engineering at Sydney University. He would be the first to admit that his education did not stop there as he became actively involved in the food industry and continues this involvement today.
Well over 1000 students were beneficiaries of John’s knowledge during his teaching career at Massey University, Hong Kong University and AUT. Many of these graduates are in leading roles in the food industry here and overseas.
He retired from his full-time academic career in 2014 as Professor at AUT and is currently an Adjunct Professor at that University. His teaching legacy includes 940 graduates in New Zealand and 280 in Hong Kong. In addition, he has run many training courses for the
food industry, specifically in HACCP and low acid canning.
He leaves a strong research legacy from his years as a microbiologist. He has published over 100 peer reviewed research papers as well as book chapters on biofilms and food safety. Many technical reports and have his name on them and he has presented papers at national and international conferences. John’s research speciality is biofilms but his interests extend to various aspects of food safety and quality, including fermentation. His publications cover work in a variety of topics including biofilms, fermented sausages, probiotic encapsulation, citric acid production, natural food preservatives, rapid microbiological tests methods, green-lipped mussel quality, foodborne pathogens and traditional Māori fermented foods.
During his academic career, he was frequently consulted on food safety and quality issues, including the Fonterra Whey Protein Concentrate issue in 2013. He has provided advice and been involved in on-site investigations for over 50 companies both in New Zealand and internationally.
While working as a consultant, he established microTech Services Ltd, which at one stage involved setting up a laboratory specifically for consultancy work. He continues his consultancy role today – it is true that a good academic never truly retires!
John has contributed to the Institute in many ways, including as an Executive member and Vice President of the Auckland Branch. He created and administered the NZIFST Facebook page until March 2021.
Outside the NZIFST, he is an honorary life member of the New Zealand Microbiological Society and was awarded the honour of Distinguished Orator – the highest award given by this organisation, at their annual meeting in 2014. He is currently a Board member of the Earl Creativity Trust that funds innovation projects in the community.
Food New Zealand 40 NZ IFST News
The Ron Hooker Award for Exemplary Service: Fiona Nyhof
Distinguished Service Award: Craig Honoré
Established to honour the outstanding voluntary contribution given by Ron Hooker to the NZIFST from its formation in 1965 until 1999, thisaward recognises significant past or current service or contribution to the NZIFST, developing the affairs of the Institute, its Branches or Divisions.
Fiona Nyhof has been a member since 1980 and has always played an active role, both at branch and national level.
Fiona has served on the Otago/Southland Branch Committee from the start of her career, as Chair for 10 of those years, and became a Fellow in 1995 in recognition of her leadership roles and contribution to NZIFST.
Not many will know this: Fiona was the first editor of the NZIFST Journal, the Food Technologist, for 5 years from 1981. She also served on the NZIFST Professional Membership Committee from 2008 to 2014.
Fiona has also has an outstanding record in the mentoring of student or younger members of the Institute both through her 27 years of teaching product development and also, for the last 8 years, through running NZIFST branded career workshops at the University of Otago.
And that’s not all…..
Fiona is a committed member of the team that organises the Food Science judging at local Science Fairs and is a key contributor to the Science of Food events held during the biannual International Science Festivals since 2002. Not only that, but as a member of the University of Otago teaching staff, for ten years, until 2020 she was project leader for Hands on at Otago, a one-week course held in January for secondary school students considering a career in the food industry. This long serving and outstanding member is clearly a worthy recipient of the Ron Hooker Award for Exemplary Service for her invaluable contributions to leadership of the Otago-Southland branch for over 43 years, promotion of the NZIFST and the food industry through teaching and community engagement, and through her remarkable contribution to teaching at the University of Otago for over 27 years.
The NZIFST Award for Distinguished Service recognises long and exceptional service and/or contribution to a NZ Food Industry sector in a scientific, technical, teaching, marketing or managerial role and is specifically for industry personnel approaching, or in, retirement.


Our winner this year has enjoyed an exemplary career providing technical leadership in the New Zealand Cheese industry.
He has always been a passionate champion of cheese, gaining an unmatched technical and sensory expertise in a vast array of cheese types. He has been at the forefront of innovation in the industry, including new product development for consumer cheeses, cheese ingredients for food manufacturers and foodservice cheese products.
He was extensively involved in the development of the proprietary technology that transformed the manufacture of IQF mozzarella shred from a process spanning weeks to a straight-through continuous process.
His first job was at Waitoa Cheese factory, joining in 1980. When he left, in 1991, he was Factory Manager. He then joined New Zealand Dairy Research Institute and over the years has held a series of senior roles at what became Fonterra Research where his main role is as Fonterra’s global cheese technology ambassador. He has been the “go-to” guy for technical trouble-shooting in key markets around the world for many years.
Not surprisingly, Craig is frequently recruited to judge local and international Cheese shows such as NZ Cheese Awards, Wisconsin World Cheese Contest and Nantwich International Cheese Awards.
Over the years Craig has led the Cheese Technology component of the Dairy Industry Graduate Training Programme (latterly the Fonterra Graduate Training programme) and Cheese Skills Courses (aimed at upskilling cheese plant operators, supervisors and managers).
In addition to his industry activities, he has always been an active supporter of dairy and food technologists through their professional organisations, initially DIANZ and, when the two organisations merged in 2004, the NZIFST. He has continuously served as Branch Secretary of these professional organisations from 1992 until just last year, 2022, providing 30 years of non-stop service to his professional peers.
August / September 2023 41
NZ IFST News
Fellows
Hamish Conway
Hamish Conway fits the mould of a quiet achiever, one who gets on with it and over time builds an impressive body of work.
He has been at Goodman Fielder for 17 years. In that time he has strengthened the company’s dairy science knowledge, particularly in stabilisation of dairy products through UHT processing and also the introduction of ultrafiltration technologies into the production of yoghurts for the New Zealand market. A number of patents have been gained relating to this work.
His expertise has also been applied to process engineering and packaging technology, in the broad picture of the company’s product range.
Outside of his daily role he has strongly supported the Auckland branch of NZIFST, hosting many events at his company’s head office and providing guidance and growth opportunities on a professional and personal level to many members over the years. Through his advocacy, Callaghan Innovation summer students have been welcomed and benefited from the opportunity to learn about the food and FMCG industries and as part of their studies and his employer also runs Graduate Programmes.
He has also served on Advisory Groups for university degree courses for Massey and University of Otago and is an executive member of the NZ Baking Association.

Jasmin Estrera has been instrumental in sharing her knowledge and passion for Food Technology and Food Safety by enabling members to visit her workplaces and share in the journey in brewing and mushrooms.
She has also been a regular judge in the Canterbury Science Fair. She has encouraged and supported school children to follow their dreams in the STEM fields.

As a passionate believer in continuous education, encouraging students, graduates and new food industry entrants to get involved in NZIFST and actively engage with events, presentations and conference, her contribution to our Institute and our industry is significant. She is a strong believer in the role of learning from each other through networking.
She has been a very active member of the local branch for many years and is one member of the committee always out to get presenters keen to share knowledge.
Lately she has been very active in trying to re-engage with local educational institutions – with notable success.
Food New Zealand 42
NZ IFST News
Jasmin Estrera
Rebecca Klee
Rebecca Klee has an outstanding combination of technical and business skills, starting with early training in food technology followed by experience in international business development and operations management.


She is also a firm advocate of our Institute, fulfilling the role of Secretary/Treasurer of the HBPB branch of NZIFST for eight years, supporting the revitalisation of the branch. Those who have worked with her describe her as always highly professional, competent, innovative and extremely helpful.
She is a tremendous supporter of young technologists and wherever possible takes the opportunity to mentor them, bringing an amazing ‘how can I help’ attitude to the food industry, always looking to help others, whether they are seeking employment, or need pointing in the right direction when looking for technical assistance. If they need an introduction to someone to aid in project work, her list of people who can help is endless.
Many younger Technologists and businesses within Hawke’s Bay have benefited from her mentoring.
Her supporters say that she is the type of person that everyone knows, and everyone admires.

August / September 2023 43 NZ IFST News
Successful candidates for the 3 Minute Pitch Competition, left to right, 3rd, Vitor da Silva, Massey University, 2nd, Emily Fanning from University of Otago and the winner of the Qualitru/Pacific Process 3-MINUTE Pitch competition, Khushboo Soni, University of Otago.
Student Poster Competition winners, left to right, 2nd, Emily Fanning, University of Otago, 1st, Thilanka Haththotuwa, University of Otago, and Sahiti Peddisetti, Lincoln University, 3rd
Industry Award:
2023 Significant Contribution to Food Safety Award: Dr Rob Lake

Dr Rob Lake has contributed immensely to food safety in New Zealand over his career. His leadership of countless food safety, foodborne illness, and food hygiene projects have made a real impact to New Zealand’s food safety system and understanding of foodborne illness.
New Zealand has a robust food safety system, which is made stronger by studies and research like that conducted by Dr Lake. His ongoing work helps New Zealanders to be confident that the food they eat is safe and suitable."
Dr Lake is a highly respected scientist whose research, particularly in estimating the burden of various foodborne illnesses, has helped New Zealand Food Safety effectively prioritise their resources. He led the 2006/07 acute gastrointestinal illness study, which has become an important public health tool.
He has also led the national study on campylobacteriosis, the outcome of which has been key in developing risk-management activities that are expected to greatly reduce the impact of campylobacteriosis on New Zealand’s health system and vulnerable people.
In light of his extensive experience, the World Health Organization invited Dr Lake to work with them on studies on campylobacteriosis and the worldwide burden of foodborne illness.
Food New Zealand 44 NZ IFST News
Dr Rob Lake, left, with Roger Cook, MPI
The 2023 Significant Contribution to Food Safety Award, sponsored by New Zealand Food Safety is presented each year at the Conference Dinner.
Branch News
Auckland
Auckland NZIFST held its Branch AGM on June 13th at the Unserhaus kitchen showroom in Parnell with Hawkins Watts as a sponsor for the event, and it was a roaring success by all accounts!



The theme of the AGM was Sik Fan Lah!, which was from the TVNZ/ NZ on Air TV series showcasing the evolution of Chinese cuisine across New Zealand over the past 150 years. ‘Sik Fan Lah!’ is a phrase from Cantonese Chinese, literally translating to ‘eat rice now!’, but generally understood to mean ‘come and eat!’ – a universal phrase used throughout many cultures within New Zealand.
After negotiating Tuesday evening Auckland traffic and AGM formalities, ably run by our branch Chair, Jess Chong, branch members were treated to a cooking masterclass by Jennifer YeeCollinson, ably supported by one of the chefs from the Wellington TV episode, Vicki Young. Jennifer kept everyone entertained with stories from her many incarnations as food technologist, nutrition and regulatory officer, culinary tour guide as well as her experiences converting recipes from the Sik Fan Lah! series into a popular cookery book.
After the demonstration, members tucked into Jenny’s delicious steamed snapper and clay pot chicken and rice, as well as numbing fried chicken (it was hot!), spicy seafood, lamb skewers, cucumber salad, and fried bread with condensed milk prepared by Mr Hao’s BBQ Skewer Restaurant in Mt Eden, while watching episodes from the TV series on the big screen.
This event was very well attended, and Auckland Branch is looking to run similar events in the future. A big thank you to Jenny and Vicki for your time and skill, and Unserhaus for hosting us. A massive special thank you as well to Hawkins Watts as well for sponsoring our event. Thank you as well to the organising committee – the team did a fantastic job, and should be very proud.
FED Talk
We also held our FED Talk at Massey University Albany on June 28th in their magnificent new Innovation Complex. The talk approached our industry from a very interesting, different perspective – startup and entrepreneurship. Ryan Bennett and Mike Wilson of Bader, a health and wellness brand who make powder blends for focus and sleep, came in to speak to us about their product development journey, and their plans or the future. Our members enjoyed the chance to learn about something they may not have much experience with and it was a great opportunity to ask more questions about the process,
What a spread!
and to see more innovation in the growing nutraceuticals space, as consumers become increasingly interested in combining wellness with food. Thank you so much to Massey University for hosting us, and in particular to Gabi Lobo and Marie Wong for organising. And of course a massive thank you to Ryan and Mike from Bader for sharing their story with our members.
The Auckland branch has a number of exciting events coming up, including our Student Careers Evening in late July, which will be presented in a slightly different format this year as we navigate engaging our student members more. We also have another factory tour in the works, and with the roaring success of the Lion Brewery tour, is set to be another show-stopper!
August / September 2023 45
Jess Chong
Anne Scott, Anny DentenerBoswell, NZIFST President Esraa El Shall and Sarina Carson at the Auckland Branch AGM
Food expert and our presenter for the evening, Jenny YeeCollinson, Vicki Young (assistant chef), Neala Hart and Auckland Branch Chair Jess Chong
NZ IFST News
Canterbury Westland
AGM and Ice Cream Presentation by Dave Rout
We opened the night with the branch AGM and reviewed the events held over a very busy and successful year. Many of the previous committee members continue to stand and be re-elected, and we welcomed a new committee member.

Following the AGM, long-standing NZIFST member Dave Rout (of Formula Foods), presented a talk on Ice Cream. He immediately got our attention with a delicious sample of vanilla ice-cream freshly churned on site and then we were ready to digest the key ingredients (essentially dairy and sugar) and processing steps for successful ice cream production:

• Homogenisation to emulsify the fat and aqueous phases.
• Ageing – by storage at 4°C overnight.
• Churning at -6°C.
• Hardening at ≤28°C for fast reduction in ice crystal formation. After expanding on these steps and why each is important, Dave shared both facts and anecdotes about his 'life and times' working for various ice cream companies. These ranged from large established corporates to small new entrants to the market, plus he had periods in consultancy. His roles included R&D, Production and Marketing, and this work took him to multiple countries including significant time living in Fiji.
Old advertising/product shots provoked plenty of discussion and reminiscing.
This informative and entertaining session wrapped up with Dave’s thoughts on non-dairy ice cream aka frozen desserts, question time and another serving of ice cream.
Margot Richards
Food New Zealand 46 NZ IFST News
Newly elected Canterbury-Westland branch committee members, from left to right: Stephanie Herbert, Robyn Marshall, Rex Johnstone, Michelle Neyra, Charlotte Sullivan, Janette Busch, Craig Houston, Margot Richards, Bob Olayo, Yuki Wadamori, Chris Davis and Jasmin Estrera. Absent: Grace Cater and Olivia Goodwillie (Student members.)
Dave Rout gave branch members a master-class in Ice-cream manufacture
Central
AGM and Marlon Dos Reis Lecture
On June 7 Central Branch members assembled to transact the necessary formalities of our Annual General Meeting and to listen to a presentation on “Hyperspectral Imaging and Associated Chemometrics” by AgResearch research scientist Dr Marlon dos Reis. Being the Annual General Meeting, in-person attendance at one of the two venues in Palmerston North and Wellington Central was required. A total of 24 members attended to provide a quorum. In his annual report, Chairman Ben (Sutherland) advised that our branch membership is “stable” at 216, then recounted the activities of the previous 12 months. He advised that there had been 11 Branch events including two facility visits, seven lectures and two social events. The current AGM and lecture made a twelfth event meaning that the branch had met on average once per month for the year, a notable achievement. Fermentation was a recurrent theme for the year including a social event at a brewery restaurant.
The meeting then moved to election of officers. The 2023/24 Central Branch Committee will comprise a nice balance of established and new blood. The new committee will be:
Chairman: Ben Sutherland (FSANZ, WLG)
Vice Chairman: Craig Honoré (Fonterra, PMR)

Secretary: Merit Mathew (Fonterra, PMR)
Reporter: Allan Main (Retired, PMR)
Committee: Clare Chandler, Grant Boston, John van den Beuken, Graeme McLeod (all WLG), Lara Matia-Merino, Richard Archer, Daniel Palfreyman, Cailing Ang (all PMR)
The committee was also granted power to co-opt further members, so if anyone reading this regrets not having made themselves available to contribute to the branch activities please contact any committee member listed here, and you will be welcomed to the fold.
Having disposed of the necessary administrative formalities Dr Marlon dos Reis was invited to speak on his specialty topic, the use of hyperspectral imaging to characterise primary produce. Hyperspectral imaging HSI is the intersection of two analytical techniques, spectroscopy and imaging and provides a new tool for characterising physical materials like food. For the spectroscopy element wavelengths in the visible and near-infrared zone are typically used and utilising a broad spectrum provides a rich source of data about the chemical and structural characteristics of a food. Application of imaging techniques then allows extensive data sets to be distilled into more readily interpreted information to provide a fingerprint of the food.
In the last decade the development of HSI received a boost and several opportunities for the food industry are becoming feasible. But its real potential in this domain is still being determined and Dr Reis operates at the international cutting edge of applying the approach to foods like meat and dairy to characterise key food attributes including quality, safety, authenticity and food processing.
The presentation provided insights to how this emerging technology might be applied to enhance characterisation and authenticate a broad cross-section of New Zealand’s primary exports including cheese, meat, honey, salmon and potatoes. The evolution of the
technique and opportunities for application in food research and in the food industry are highlighted.
Dr Reis’s initial work with HSI was directed to developing a tool to assess quality of meat and to track how farming and processing practices directly impact product quality. Since that focus realisation has dawned that HSI can be extended to other flesh systems (eg salmon) and even to non-flesh foods like cheese, honey and vegetables. HSI now shows promise as a generic tool for quality determination in foods of the future using HIS as a fingerprinting technology. This presentation provided an intriguing window on how New Zealand’s food industry of the future may have the means to validate both the quality and provenance attributes on which New Zealand food produce increasingly relies to extract a proprietary premium position in an increasingly demanding global food market. Hyperspectral imaging provides a new tool for non-invasive and rapid characterisation of food attributes for safety, authentication and quality assurance.
Congratulations National Award Recipients
At our 2023 National Conference two Central Branch members, Dr John Brooks and Craig Honoré, each received a significant recognition. John was the recipient of the 2023 J C Andrews award, recognising his nearly 50-year career in industrial microbiology and food technology education with particular impact on food safety. Craig was awarded a Distinguished Service award for his long and exemplary leadership in the New Zealand Cheese Industry spanning over 40 years.
John and Craig, your Central Branch colleagues extend our heartfelt congratulations to you both for these well-earned prestigious awards. We also extend our congratulations to all other NZIFST members recognised at the annual conference dinner.
Allan Main FNZIFST
August / September 2023 47 NZ IFST News
Dr Marlon dos Reis of AgResearch addresses NZIFST Central Branch at the conclusion of the AGM
Otago/Southland
On the 15th of June 2023, the Otago/Southland Branch gathered at the University of Otago, Dunedin, for its AGM. The AGM set the stage for a captivating seminar by Anne Gatenby, who shared insights from her career journey encompassing yeast, beer, cocoa, and sustainability. Pat Silcock, the Branch Chair at that time, expressed pride in the branch's achievements, crediting the surge of activities and national events amid the waning influence of the pandemic. The AGM also marked the selection of new committee members. Graham Eyres was elected as the new Chair, succeeding Pat Silcock. Pat's committed service and contributions as Chair for the past decade and as a committee member for two decades garnered heartfelt appreciation from both Graham and the audience.

The Branch Committee for 2023/2024:
Chair: Graham Eyres,
Secretary: Biniam Kebede
Treasurer: Brigitte Legg
Southland Rep: Matt Steven
Social media: Supriya Sally
Board Rep: Pat Silcock
Committee members: Aladin Bekhit, Dominic Agyei, Anne Gatenby, Hannah Browne (student), Rebecca Roberts (student), Jessica O’Connor (student).
Following the AGM, Anne Gatenby, the Sustainability Analyst at Silver Fern Farms, delivered an engaging and well-received talk, reflecting on her career journey. Anne is an Otago graduate who has worked for Lion, Cadbury, Nestle, Anheuser-Busch, and Emerson’s both in New Zealand and overseas. The event concluded on a high note, with attendees savouring nibbles and refreshments while mingling and networking.
Biniam Kebede
Food New Zealand 48 NZ IFST News
Anne Gatenby shared insights from her career journey encompassing yeast, beer, cocoa, and sustainability with Branch members at the AGM
Waikato
Unravelling the magic of sourdough at Volare Breads
The NZIFST Waikato Branch had an enchanting site visit tour on 30th and 31st of May to Volare Breads, a celebrated sourdough bakery in Hamilton. The Volare family was conceived in 2009 by two old school mates, Ed and Ryan. The dream was to create a Traditional Artisan Bakery that produced the highest quality sourdough bread, pastries, and cakes, all at affordable prices. With one old oven, a tired mixer, and a clapped-out old van their dream began. Volare is now the Waikato and Bay of Plenty’s premier Artisan Bakery, distributing to cafés, restaurants, and good food stores in the area.
With 24 eager participants, the tour promised an immersive experience into the art of crafting sourdough delights, and it certainly delivered. The tour was led by passionate lead baker, and the tour showcased the bakery's commitment to quality and its focus on sourdough fermentation. Participants witnessed the hands-on artistry behind each sourdough loaf and learned about the science of sourdough's fermentation. We were also given sourdough starter cultures to take home.
The highlight was the taste test of warm, buttery flaky croissants, leaving everyone captivated by the perfect balance of flavours. The site visit tour was a delightful celebration of sourdough baking, and participants departed with hearts full of gratitude and unforgettable memories.


AGM and NPD presentations by Wintec students
The recent Waikato Branch Annual General Meeting was a successful event that brought together professionals and enthusiasts in the field of food science and technology. The AGM was held at TetraPak, Ruakura. Prior to the AGM, attendees were treated to a series of insightful presentations by the talented Wintec Food Technology Students. These presentations focused on new food product development, and what made them even more exciting was the opportunity for attendees to taste some of these innovative creations. The students showcased their innovative ideas and research findings, impressing the audience with their creativity and dedication. The presentations highlighted the importance of continuous advancement in the food industry and sparked engaging discussions among the participants.
Chathurika Samarakoon
August / September 2023 49 NZ IFST News
Waikato Branch members at Volare ready for their tour and tasting
Precision Fermentation: Cultivating the Future of Dairy
Erin Lau, Student, The University of Auckland, Food Science Programme
This article was awarded first prize in the Food Tech Solutions NZIFST Undergraduate Writing Competition 2023. The annual competition is open to undergraduate food science and food technology students who are invited to write on any technical subject or latest development in the food science and technology field that may be of interest.

Milk products have been a key staple in the human diet for millennia. Besides supplying a nutritionally complete source of protein, fats, vitamins and minerals, dairy production supports the livelihoods of countless communities and the economic prosperity of New Zealand. In 2020, it accounted for 20% of New Zealand exports (New Zealand Productivity Commission, 2020). So why fix something that's not broken?
What is precision fermentation?
Precision fermentation technology uses genetic engineering to modify the DNA of unicellular microorganisms, transforming them into "cell factories" that produce high-value compounds (Augustin et al., 2023). Despite its futuristic namesake, precision fermentation is not new. In 1990, the FDA first approved recombinant DNA technology to produce non-calf rennet. By 2006, this product comprised as much as 80% of the worldwide rennet market share (Johnson & Lucey, 2006) and remains popular amongst today's cheesemakers. Precision fermentation has been touted as a revolutionary method
to create a product similar to dairy milk in terms of flavour, function and nutrition at a fraction of the space, time and resources associated with agricultural farming (Tubb & Seba, 2021). The process begins with identifying the specific proteins in milk that will be produced via microbial fermentation – commonly casein or whey proteins. The specific genes encoding these milk proteins are extracted from a single bovine cell and inserted into the DNA of microorganisms that are generally regarded as safe (Augustin et al., 2023). The recombinant microbes are suspended in a nutrient-rich medium where the substrates are metabolised, producing milk proteins. Following microbial fermentation, the medium containing the microbes and fermentation products is filtered and purified to isolate the milk proteins. They are subsequently concentrated and dried to produce a potent, high-quality protein ingredient (Pandya et al., 2020).
In 2020, U.S. biotechnology start-up, Perfect Day was the first to use precision fermentation to commercialise β-lactoglobulin production, a whey protein that contributes to milk's flavour, mouthfeel and nutritional properties (Waltz, 2022). An animal-free milk alternative was created using Perfect Day's proteins and a blend of water,

Food New Zealand 50 Student Essay
Milk products have been a key staple in the human diet for millennia
vegetable fats, sugar, vitamins and minerals, making it similar in function and nutrition to its bovine counterpart whilst being lactose-free and vegan (Pandya et al., 2020). Milk proteins derived from precision fermentation can be incorporated into many food and beverage applications, such as ice cream, milk, yoghurt, cheese, chocolate and protein powder instead of typical dairy ingredients.
Is precision fermentation the future of dairy?
Dairy milk is considered an ideal source of nutrition, and much of its appeal stems from its versatility in high-value, derivative applications like cheese, cream and butter. Environmental, ethical and health concerns related to dairy farming and consumption have contributed to the recent popularity of plant-based alternatives. However, existing options often fall short based on nutrition, flavour and functionality (Smith et al., 2022).
The extraction of whey protein via microbial fermentation claims to reduce greenhouse gas emissions by 91% to 97%, consume 29% to 60% less energy and 96% to 99% less water when compared to the grass-to-glass analysis of bovine milk protein (Perfect Day, 2021). Since Perfect Day's life cycle assessment is based on the company's sole environmental impact, it omits the burdens of substrate production and the downstream supply chain after ingredient distribution. To shift even a small amount of the world's milk demand to fermented alternatives would require a significant scaling up. Wood and Tavan (2021) estimate that producing 1 billion litres of precision-fermented milk would require NZ$600 million in fermentation equipment alone, excluding staff, facility costs and materials. Moreover, additional ingredients and sterilisation costs would result in a final product that is more than triple the price of regular milk (Bored Cow, 2022). Amidst challenging economic conditions, the ethical and environmental benefits of animal-free milk alternatives must be significant enough for consumers to justify the premiums on a typically inexpensive grocery staple.
How can precision fermentation benefit New Zealand?
Precision fermentation of dairy ingredients presents an opportunity for New Zealand to diversify its current exports. Over 80% of the companies currently developing fermentation applications were established in the past six years (Day et al., 2022), indicative of the industry's rapid growth and expansion. New Zealand's strong track record for dairy technology and fermentation knowledge are synergistic factors that could lead to world-first innovations in precision fermentation. Daisy Lab, a recent NZ start-up, has led New Zealand's precision fermentation efforts by producing casein proteins and is projected to enter the market around 2024 (Day et al., 2022). If New Zealand were to become early adopters of precision fermentation, our "clean green" image could be leveraged to meet consumer demands for ethical food products that are sustainably produced. However, the historical importance of traditional dairy to New Zealand's farming communities and economy means precision fermentation is not yet capable of entirely replacing dairy. Nonetheless, it offers exciting alternatives that closely mimic the properties of bovine milk for consumers with dietary restrictions or who wish to lessen their environmental impacts. The continual R&D process will undoubtedly generate exciting microbial fermentation
discoveries in the future, which could position New Zealand as a hub for biotechnological innovation, collaboration and investment.
Conclusion
Precision fermentation lends itself readily to the production of proteins, lipids, carbohydrates and flavouring agents due to its ability to synthesise molecules that mimic the composition of their animal counterparts. The potentiality of this technology calls for governmental support of preliminary R&D and revisions to GE and GMO policies to usher in a new era of food innovation.
In summary; the future of food is happening right before our eyes, but we might need a microscope!
References
Augustin, M. A., Hartley, C. J., Maloney, G., & Tyndall, S. (2023). Innovation in precision fermentation for food ingredients. Critical Reviews in Food Science and Nutrition, 1–21. https://doi.org/10.108 0/10408398.2023.2166014
Bored Cow. (2022). Bored Cow | “The first milk alternative to do it all.” Tryboredcow.com. https://tryboredcow.com/
Day, L., Altermann, E., Chanyi, R., Hicks, T., Knowles, S., & Mullaney, J. (2022). Fermentation for future food systems -What are the opportunities for New Zealand? https://www.agresearch.co.nz/ assets/Uploads/Fermentation-for-future-food-systems.pdf
Johnson, M. E., & Lucey, J. A. (2006). Major Technological Advances and Trends in Cheese. Journal of Dairy Science, 89(4), 1174–1178. https://doi.org/10.3168/jds.s0022-0302(06)72186-5
New Zealand Productivity Commission. (2020). The Dairy Sector in New Zealand Extending the Boundaries. In New Zealand Productivity Commission. https://www.productivity.govt.nz/assets/ Inquiries/frontier-firms/a977484e51/The-dairy-sector-in-NZ-TDBAdvisory.pdf
Pandya, R., Gandhi, P., Ji, S., Beauchamp, D., & Hom, L. (2020). Compositions comprising a-casein and methods for producing the same. https://patentimages.storage.googleapis.com/fc/c0/fc/ 2eb02402e8737e/US10595545.pdf
Perfect Day. (2021, April 18). The Life Cycle of Our Non Animal Protein. Perfect Day. https://perfectday.com/blog/life-cycleassessment-of-perfect-day-protein/
Smith, N. W., Dave, A. C., Hill, J. P., & McNabb, W. C. (2022). Nutritional assessment of plant-based beverages in comparison to bovine milk. Frontiers in Nutrition, 9. https://doi.org/10.3389/ fnut.2022.957486
Tubb, C., & Seba, T. (2021). Rethinking Food and Agriculture
2020-2030: The Second Domestication of Plants and Animals, the Disruption of the Cow, and the Collapse of Industrial Livestock Farming. Industrial Biotechnology, 17(2), 57–72. https://doi. org/10.1089/ind.2021.29240.ctu
Waltz, E. (2022). Cow-less milk: the rising tide of animal-free dairy attracts big players. Nature Biotechnology, 40(11), 1534–1536. https://doi.org/10.1038/s41587-022-01548-z
Wood, P., & Tavan, M. (2021). The changing face of protein production. New Zealand Science Review, 77(3-4), 60–62. https:// doi.org/10.26686/nzsr.v77i3-4.7773
August / September 2023 51 Student Essay
NZIFST CONFERENCE 2024

Your suggestions for topics of interest are welcome
Conference Committee Chair is Rob Archibald
Build your network, build your knowledge, diversify your experience
For more information contact NZIFST, wendy@nzifst.org.nz
Food New Zealand 52